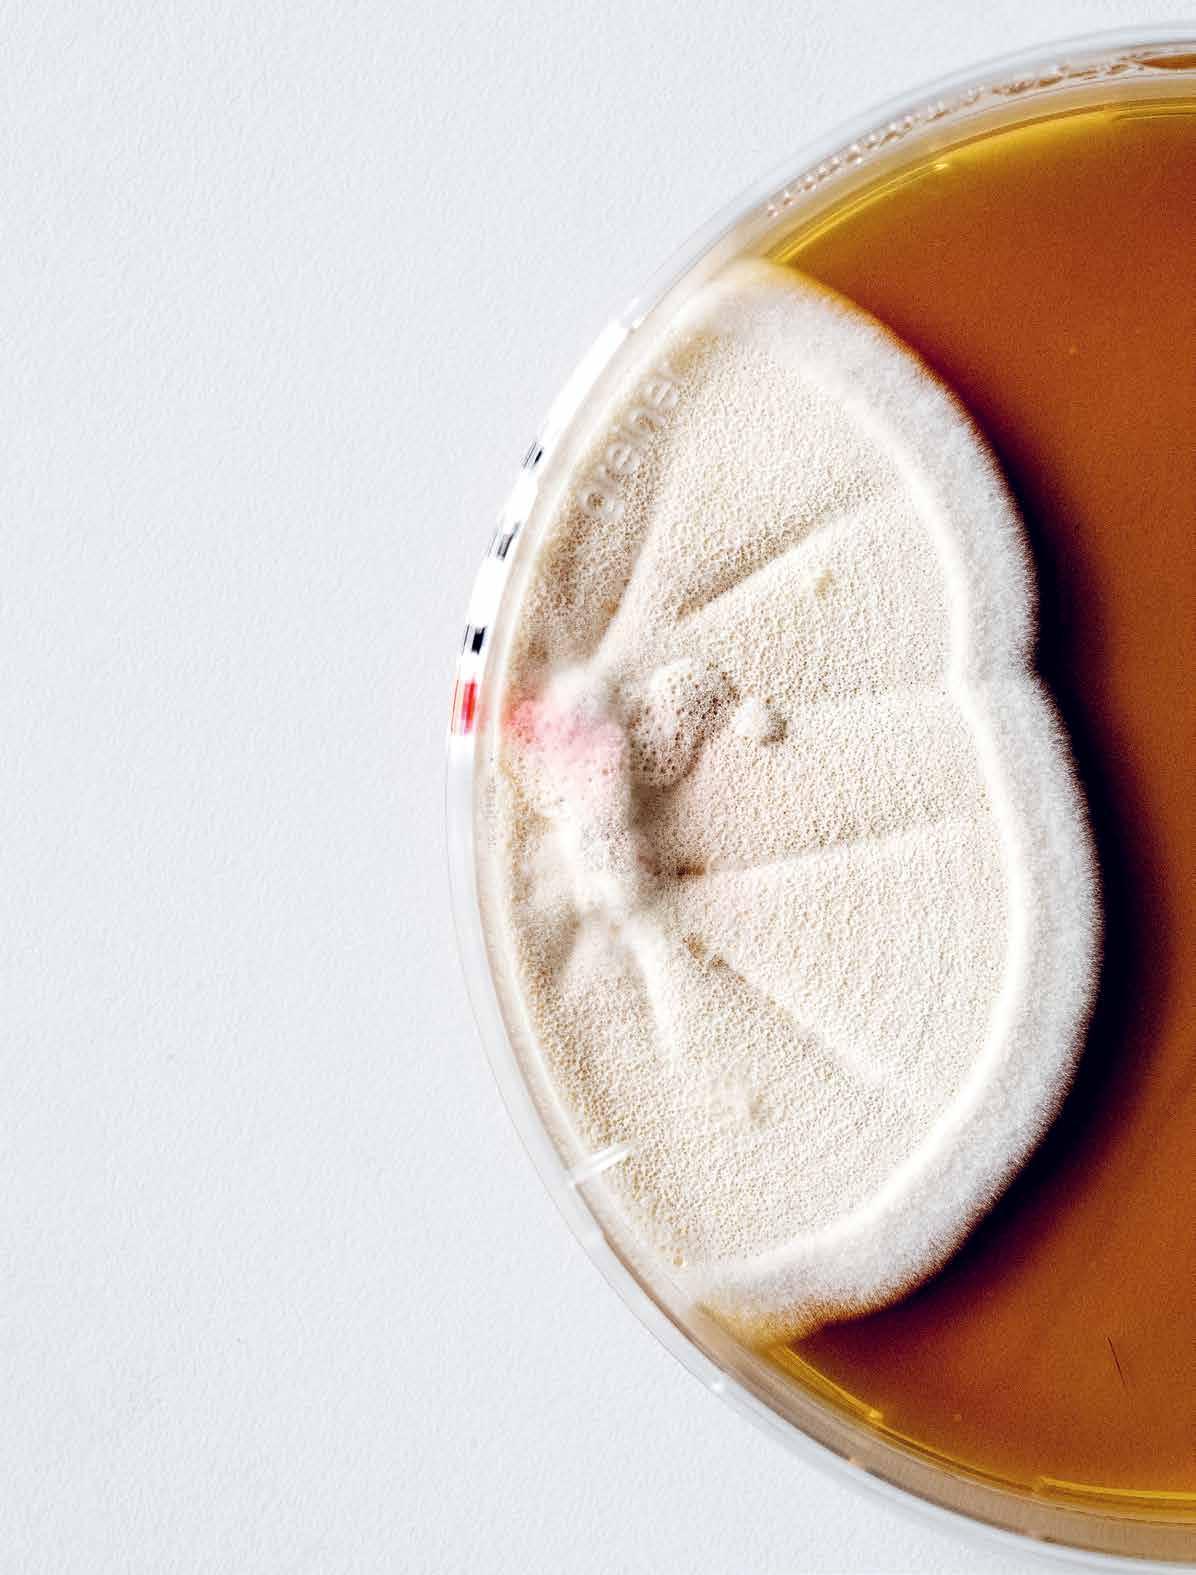

DTU ÅRSRAPPORT 2025
målinger i Grønland
og klimarelaterede
Permafrost-

I mere end 25 år har DTU været til stede i Grønland med forskning, uddannelse og rådgivning, der understøtter samfundets behov i et arktisk klima. DTU driver i dag en række permafrost- og klimarelaterede målepunkter i området mellem Sisimiut og Kangerlussuaq, som giver værdifuld viden om ændringer i jordbund, temperaturer, snedække og stabilitet i terrænet. Disse data er afgørende for at forstå de igangværende klimaforandringer og indgår i internationale modeller, der belyser, hvordan ændringer i og omkring Grønland påvirker det globale klima og levevilkårene for både arktiske samfund og befolkningen på den nordlige halvkugle.
01 Påtegning
8 Ledelsespåtegning
10 Den uafhængige revisors revisionspåtegning
02 Beretning
14 Institutionsoplysninger
16 Præsentation af institutionen
18 Ledelsesberetning
18 – Årets faglige resultater
32 – Årets økonomiske resultat
38 Afrapportering på Strategisk rammekontrakt 2022-2025
44 Forventninger til det kommende år
03 Regnskab
48 Anvendt regnskabspraksis
53 Resultatopgørelse inkl. noter
54 Balance inkl. noter
56 Egenkapital
57 Pengestrømsopgørelse
68 Særlige specifikationer
04 Bilag
72 Grønt regnskab
84 Personale og arbejdsmiljø
88 Bestyrelsens og direktionens bestyrelsesposter i selskaber, fonde m.v.
Indtægter
DTU havde indtægter for i alt
6,7 mia. kr.
Forskning (Statstilskud)
27 pct.
Forskning (Konkurrenceudsatte midler)
42 pct.
Øvrige indtægter
3 pct.

Uddannelse 16 pct.
Forskningsbaseret myndighedsbetjening
3 pct.
Salg af varer og tjenesteydelser
9 pct.
763 studerende på diplomingeniøruddannelsen Optag
1.260
2.843 studerende på kandidatuddannelsen studerende på bacheloruddannelsen
117
nye start-ups er skabt baseret på viden og teknologi fra DTU i 2025
Årsværk i alt:
6.574
DTU har aktiviteter i hele Danmark samt i Grønland. Hovedcampus er i Kgs. Lyngby
102
Universitetet favner forskellige nationaliteter
Skive
Frederikshavn
Udvikling i optag 2022-2025
Diplomingeniør-
Fredericia
Bornholm Hirtshals
Kalundborg
Rødbyhavn
Ballerup Risø
Campusser Residential Colleges
Lyngby
2.940 ingeniører dimitterede fra DTU i 2025
13.808 studerende er indskrevet på universitetet

01 Påtegning
· Ledelsespåtegning
· Den uafhængige revisors revisionspåtegning

På Ballerup Campus tager studerende sig en velfortjent pause mellem studierne. Det kan f.eks. være studerende fra Innovation Pilot, der præsenterer deres idéer og koncepter for virksomheder, der søger nye perspektiver på tekniske udfordringer.
Direktionen





Carsten Orth Gaarn-Larsen Koncerndirektør (nationale og internationale partnerskaber, og livslang læring)

Rygaard-Hjalsted Dekan (bæredygtighed, diversitet, inklusion og talentudvikling)
Årsrapporten er udarbejdet i overensstemmelse med lov om statens regnskabsvæsen m.v., bekendtgørelse nr. 116 af 19. februar 2018 om statens regnskabsvæsen mv., de nærmere retnings-linjer i Finansministeriets Økonomisk Administrative Vejledning, bekendtgørelse af lov om universiteter (universitetsloven) LBK nr. 391 af 10/04/2024, bekendtgørelse om tilskud og revision m.v. ved universiteterne (tilskuds- og revisionsbekendtgørelsen) BEK nr. 912 af 25/06/2025 samt Uddannelses- og Forskningsstyrelsens retningslinjer for udarbejdelse af årsrapport.
I henhold til § 39, stk. 4, nr. 1-3 i bekendtgørelse om statens regnskabsvæsen BEK nr. 116 af 19/02/2018 (regnskabsbekendtgørelsen) tilkendegives det:

Thellersen
(innovation og entrepreneurskab)
- At årsrapporten er rigtig, dvs., at årsrapporten ikke indeholder væsentlige fejlinformationer eller udeladelser, herunder at målopstillingen og målrapporteringen i årsrapporten er fyldestgørende.
- At de dispositioner, som er omfattet af regnskabsaflæggelsen, er i overensstemmelse med meddelte bevillinger, love og andre forskrifter samt med indgåede aftaler og sædvanlig praksis.
- At der er etableret forretningsgange, der sikrer en økonomisk hensigtsmæssig forvaltning af de midler og ved driften af de institutioner, der er omfattet af årsrapporten.
Kgs. Lyngby den 7. april 2026
Anders Overgaard Bjarklev Rektor
Lars D. Christoffersen Dekan (uddannelser og studiemiljø)
Anders Overgaard Bjarklev Rektor
Marianne
Koncerndirektør
Claus Nielsen Universitetsdirektør
Camilla
Christine Nellemann Prorektor
Bestyrelsen










Bestyrelsen Kgs. Lyngby den 7. april 2026





Asmus Jarl Møller Christensen bestyrelsesleder





Kasper Moth-Poulsen
Annekatrine Kirketerp-Møller
Ulrik Juul Christensen Henrik Clausen
Ole Sigmund
Margrethe Vestager, bestyrelsesleder
Asmus Jarl Møller Christensen Ulrik Juul Christensen
Marianne Dahl
Ole Sigmund
Charlotte Rønhof
Marianne Dahl
Kasper Moth-Poulsen
Annekatrine Kirketerp-Møller
Nina Kjærgaard Hendel
Henrik Clausen
Den uafhængige revisors revisionspåtegning
TIL BESTYRELSEN FOR DTU
Konklusion
Vi har revideret årsregnskabet for DTU for regnskabsåret 1. januar - 31. december 2025, der omfatter anvendt regnskabspraksis, resultatopgørelse, balance, egenkapitalopgørelse, pengestrømsopgørelse og noter. Årsregnskabet udarbejdes efter statens regnskabsregler og bekendtgørelse nr. 912 af 25. juni 2025 om tilskud og revision m.v. ved universiteterne (statens regnskabsregler).
Det er vores opfattelse, at årsregnskabet i alle væsentlige henseender er rigtigt, dvs. udarbejdet i overensstemmelse med statens regnskabsregler.
Grundlag for konklusion
Vi har udført vores revision i overensstemmelse med internationale standarder om revision og de yderligere krav, der er gældende i Danmark, samt standarderne for offentlig revision, idet revisionen udføres på grundlag af bestemmelserne i statens regnskabsregler. Vores ansvar ifølge disse standarder og krav er nærmere beskrevet i revisionspåtegningens afsnit Revisors ansvar for revisionen af årsregnskabet. Det er vores opfattelse, at det opnåede revisionsbevis er tilstrækkeligt og egnet som grundlag for vores konklusion.
Uafhængighed
Vi er uafhængige af universitetet i overensstemmelse med internationale etiske regler for revisorer (IESBA’s etiske regler) og de yderligere krav, der er gældende i Danmark, ligesom vi har opfyldt vores øvrige etiske forpligtelser i henhold til disse regler og krav.
Ledelsens ansvar for årsregnskabet
Ledelsen har ansvaret for udarbejdelsen af et årsregnskab, der i alle væsentlige henseender er rigtigt, dvs. udarbejdet i overensstemmelse med statens regnskabsregler. Ledelsen har endvidere ansvaret for den interne kontrol, som ledelsen anser for nødvendig for at udarbejde et årsregnskab uden væsentlig fejlinformation, uanset om denne skyldes besvigelser eller fejl.
Ved udarbejdelsen af årsregnskabet er ledelsen ansvarlig for at vurdere universitetets evne til at fortsætte driften; at oplyse om forhold vedr. fortsat drift, hvor dette er relevant; samt at udarbejde årsregnskabet på grundlag af regnskabsprincippet om fortsat drift, medmindre ledelsen enten har til hensigt at likvidere universitetet, indstille driften eller ikke har andet realistisk alternativ end at gøre dette.
Revisors ansvar for revisionen af årsregnskabet
Vores mål er at opnå høj grad af sikkerhed for, om årsregnskabet som helhed er uden væsentlig fejlinformation, uanset om denne skyldes besvigelser eller fejl, og at afgive en revisionspåtegning med en konklusion. Høj grad af sikkerhed er et højt niveau af sikkerhed, men er ikke en garanti for, at en revision, der udføres i overensstemmelse med internationale standarder om revision og de yderligere krav, der er gældende i Danmark, samt standarderne for offentlig revision, jf. statens regnskabsregler, altid vil afdække væsentlig fejlinformation, når sådan findes. Fejlinformationer kan opstå som følge af besvigelser eller fejl og kan betragtes som væsentlige, hvis det med rimelighed kan forventes, at de enkeltvis eller samlet har indflydelse på de økonomiske beslutninger, som regnskabsbrugerne træffer på grundlag af årsregnskabet. Som led i en revision, der udføres i overensstemmelse med internationale standarder om revision og de yderligere krav, der er gældende i Danmark, samt standarderne for offentlig revision, jf. statens regnskabsregler foretager vi faglige vurderinger og opretholder professionel skepsis under revisionen. Herudover:
• Identificerer og vurderer vi risikoen for væsentlig fejlinformation i årsregnskabet, uanset om denne skyldes besvigelser eller fejl, udformer og udfører revisionshandlinger som reaktion på disse risici samt opnår revisionsbevis, der er tilstrækkeligt og egnet til at danne grundlag for vores konklusion. Risikoen for ikke at opdage væsentlig fejlinformation forårsaget af besvigelser er højere end ved væsentlig fejlinformation forårsaget af fejl, idet besvigelser kan omfatte sammensværgelser, dokumentfalsk, bevidste udeladelser, vildledning eller tilsidesættelse af intern kontrol.
• Opnår vi forståelse af den interne kontrol med relevans for revisionen for at kunne udforme revisionshandlinger, der er passende efter omstændighederne, men ikke for at kunne udtrykke en konklusion om effektiviteten af universitetets interne kontrol.
• Tager vi stilling til, om den regnskabspraksis, som er anvendt af ledelsen, er passende, samt om de regnskabsmæssige skøn og tilknyttede oplysninger, som ledelsen har udarbejdet, er rimelige.
• Konkluderer vi, om ledelsens udarbejdelse af årsregnskabet på grundlag af regnskabsprincippet om fortsat drift er passende, samt om der på grundlag af det opnåede revisionsbevis er væsentlig usikkerhed forbundet med begivenheder eller forhold, der kan skabe betydelig tvivl om universitetets evne til at fortsætte driften. Hvis vi konkluderer, at der er en væsentlig
usikkerhed, skal vi i vores revisionspåtegning gøre opmærksom på oplysninger herom i årsregnskabet eller, hvis sådanne oplysninger ikke er tilstrækkelige, modificere vores konklusion. Vores konklusioner er baseret på det revisionsbevis, der er opnået frem til datoen for vores revisionspåtegning. Fremtidige begivenheder eller forhold kan dog medføre, at universitetet ikke længere kan fortsætte driften.
Vi kommunikerer med den øverste daglige ledelse om blandt andet det planlagte omfang og den tidsmæssige placering af revisionen samt betydelige revisionsmæssige observationer, herunder eventuelle betydelige mangler i intern kontrol, som vi identificerer under revisionen.
Udtalelse om ledelsesberetningen og samlet opgørelse af målopfyldelse for DTU’s strategiske rammekontrakt 2022-2025
Ledelsen er ansvarlig for ledelsesberetningen [side 18], herunder samlet opgørelse af målopfyldelse for DTU’s strategiske rammekontrakt 2022-2025 [side 38].
Vores konklusion om årsregnskabet omfatter ikke ledelsesberetningen, og vi udtrykker ingen form for konklusion med sikkerhed om ledelsesberetningen.
I tilknytning til vores revision af årsregnskabet er det vores ansvar at læse ledelsesberetningen og i den forbindelse overveje, om ledelsesberetningen er væsentlig inkonsistent med årsregnskabet eller vores viden opnået ved revisionen eller på anden måde synes at indeholde væsentlig fejlinformation.
Vores ansvar er derudover at overveje, om ledelsesberetningen indeholder de krævede oplysninger i henhold til statens regnskabsregler.
Baseret på det udførte arbejde er det vores opfattelse, at ledelsesberetningen er i overensstemmelse med årsregnskabet og er udarbejdet i overensstemmelse med kravene i statens regnskabsregler. Vi har ikke fundet væsentlig fejlinformation i ledelsesberetningen.
Erklæring i henhold til anden lovgivning og øvrig regulering Udtalelse om juridiskkritisk revision og forvaltningsrevision Ledelsen er ansvarlig for, at de dispositioner, der er omfattet af regnskabsaflæggelsen, er i overensstemmelse med meddelte bevillinger, love og andre forskrifter samt med indgåede aftaler og sædvanlig praksis. Ledelsen er også ansvarlig for, at der er taget skyldige økonomiske hensyn ved forvaltningen af de midler og driften af de aktiviteter, der er omfattet af årsregnskabet. Ledelsen har i den forbindelse ansvar for at etablere systemer og processer, der understøtter sparsommelighed, produktivitet og effektivitet.
I tilknytning til vores revision af årsregnskabet er det vores ansvar at gennemføre juridiskkritisk revision og forvaltningsrevision af udvalgte emner i overensstemmelse med standarderne for offentlig revision. I vores juridiskkritiske revision efterprøver vi med høj grad af sikkerhed for de udvalgte emner, om de undersøgte dispositioner, der er omfattet af regnskabsaflæggelsen, er i overensstemmelse med de relevante bestemmelser i bevillinger, love og andre forskrifter samt indgåede aftaler og sædvanlig praksis. I vores forvaltningsrevision vurderer vi med høj grad af sikkerhed, om de undersøgte systemer, processer eller dispositioner understøtter skyldige økonomiske hensyn ved forvaltningen af de midler og driften af de aktiviteter, der er omfattet af årsregnskabet.
Hvis vi på grundlag af det udførte arbejde konkluderer, at der er anledning til væsentlige kritiske bemærkninger, skal vi rapportere herom i denne udtalelse.
Vi har ingen væsentlige kritiske bemærkninger at rapportere i den forbindelse.
Kgs. Lyngby den 7. april 2026
EY Godkendt Revisionspartnerselskab
CVR-nr. 30 70 02 28


Rasmus Friborg Andersen Statsautoriseret revisor Statsautoriseret revisor

02 Beretning
· Institutionsoplysninger
· Præsentation af institutionen
· Ledelsesberetning
– Årets faglige resultater
– Årets økonomiske resultat
· Afrapportering på Strategisk rammekontrakt 2022-2025
· Forventninger til det kommende år

I DTU’s lyddøde rum kan forskere undersøge lyd i sin reneste form uden ekko, støj eller refleksioner. Faciliteterne muliggør kreative eksperimenter og innovative projekter, der kan forbedre fremtidens lydteknologier.
Professor Lone Gram og forskere fra CeMiSt har bidraget med faglig viden til Amalie Smiths kunstværk Levende jord på Viborg Gymnasium. Her bliver jordens mikroskopiske samfund af bakterier, svampe og planterødder gengivet i kæmpeformat som et 252 m² stort terrazzogulv. Værket gør det usynlige synligt og inviterer eleverne til at udforske mikrobiologiens fascinerende verden.

Institutionsoplysninger
INSTITUTIONEN
Danmarks Tekniske Universitet
Anker Engelunds Vej 1 2800 Kgs. Lyngby
Telefon 45 25 25 25
Kontaktformular: https://www.dtu.dk/om-dtu/ kontakt-og-besoeg/kontakt
CVR-nr. 30 06 09 46
REGNSKABSÅR
Regnskabsår: 2025
HJEMSTEDSKOMMUNE
Lyngby-Taarbæk Kommune
BANK
Danske Bank
Holmens Kanal 2 – 12 1092 København K
Reg.nr. 4183
Kontonr. 4263972007
INSTITUTIONSREVISOR
ERNST & YOUNG
Godkendt Revisionspartnerselskab Dirch Passers Allé 36, 2000 Frederiksberg
Bestyrelse
PR. 1. FEBRUAR 2026
Margrethe Vestager
Bestyrelsesleder, Fhv. konkurrencekommissær og ledende næstformand af EU-Kommissionen. World Leaders Fellow, Blavatnik School of Government, Oxford Universitet
Asmus Jarl Møller Christensen
Stud.polyt. Valgt af og blandt de studerende
Ulrik Juul Christensen
Bestyrelsesformand og adm. direktør, Area9 Lyceum
Henrik Clausen
Professionelt bestyrelsesmedlem
Marianne Dahl
Professionelt bestyrelsesmedlem og Senior Tech Advisor, BCG
Nina Kjærgaard Hendel
Chefkonsulent. Valgt af og blandt det teknisk-administrative personale på DTU
Annekatrine Kirketerp-Møller
Stud.polyt. Valgt af og blandt de studerende
Kasper Moth-Poulsen
ICREA professor på Polytechnic University of Catalonia og professor på Chalmers University of Technology
Charlotte Rønhof
Professionelt bestyrelsesmedlem
Ole Sigmund
Professor og Villum Investigator. Valgt af og blandt det videnskabelige personale på DTU
Direktion
1. FEBRUAR 2026
Anders Overgaard Bjarklev Rektor
Christine Nellemann Prorektor
Claus Nielsen
Universitetsdirektør
Marianne Thellersen Koncerndirektør for Innovation og Entrepreneurskab
Lars D. Christoffersen Dekan for Uddannelser og Studiemiljø
Carsten Orth Gaarn-Larsen Koncerndirektør for Nationale og Internationale Partnerskaber og Livslang Læring
Camilla Rygaard-Hjalsted Dekan for Bæredygtighed, Diversitet, Inklusion og Talentudvikling
Præsentation af institutionen
Ledelsesgrundlag
DTU's bestyrelse fastlægger de langsigtede retningslinjer for universitetet og består af ti medlemmer, heraf seks eksterne medlemmer, to medarbejdere og to studerende. Bestyrelsens eksterne medlemmer udpeges for en fireårig periode via et indstillings- og udpegningssystem. Medarbejder- og studenterrepræsentanterne vælges for hhv. en fireårig og toårig periode.
Derudover er der nedsat et repræsentantskab, der årligt drøfter universitetets aktiviteter. Repræsentantskabet består af 16 medlemmer, som vælges fra institutdirektørernes advisory boards for en fireårig periode. Tilsvarende drøfter DTU’s aftagerpanel universitetets uddannelser, herunder uddannelsernes kvalitet og relevans samt udvikling af nye og eksisterende uddannelser. Panelet består af 33 medlemmer og udpeges for en treårig periode. Repræsentantskabet og aftagerpanelet repræsenterer erhvervsliv, myndigheder og forskningsverdenen i bred forstand.
DTU's kollegiale organer, herunder akademisk råd, institutstudienævn, tværgående uddannelsesudvalg og ph.d.-udvalg, har valgte repræsentanter for det videnskabelige personale og de studerende. Universitetets samarbejdsfora, hovedsamarbejdsudvalget og hovedarbejdsmiljøudvalget har valgte medarbejderrepræsentanter. Hovedarbejdsmiljøudvalget har tillige valgte studenterrepræsentanter.
Bestyrelse
10 medlemmer (6 eksterne medlemmer, 2 medarbejdere og 2 studerende)
Aftagerpanel
33 medlemmer fra erhvervsliv, myndigheder og forskningsverdenen
Universitetets ledelse er kendetegnet ved en enstrenget ledelsesstruktur, der understøtter "single point of responsibility" ved en vidtgående delegering af ansvar og kompetence til institutdirektører og direktører for andre universitetsenheder. Prorektor, koncerndirektører og dekanerne har på tværs af institutternes og centrenes faglige felter ansvaret for koordinering af uddannelse, forskning, forskningsbaseret rådgivning og innovation. DTU's beslutningsveje er korte, og alle institutter samt andre universitetsenheder refererer til direktionen under ledelse af rektor, der er ansvarlig for den daglige ledelse af universitetet over for bestyrelsen.
Det strategiske ledelsesgrundlag består af DTU’s Strategi 2026-2031 Til gavn for samfundet siden 1829, hvor der arbejdes med fem strategiske indsatsområder: Bæredygtig teknologisk omstilling; Europæisk førerskab i kritiske teknologier; Uddannelse af Europas mest kompetente ingeniører; Fra viden til virksomhed samt at DTU påtager sig videnskabeligt lederskab og demokratisk ansvar. Universitetet har desuden indgået en strategisk rammekontrakt med uddannelses- og forskningsministeren for 2022-2025, som er blevet forlænget til 2026. DTU’s Årsrapport 2025 gennemgår den samlede opgørelse af målopfyldelse for DTU’s strategiske rammekontrakt og de økonomiske resultater i tidsperioden 1. januar til 31. december 2025.
Repræsentantskab
16 medlemmer fra institutdirektørernes advisory boards
Kollegiale organer
Akademisk råd, institut studienævn, tværgående uddannelsesudvalg og ph.d.-udvalg
Hovedopgaver
DTU er et teknisk eliteuniversitet, der er kendetegnet ved forskning og uddannelse på højeste internationale niveau, professorer med forskningsledelse, tæt samspil med myndigheder og erhvervslivet, samt strategiske alliancer med samarbejdspartnere i Danmark og internationalt.
DTU er et globalt orienteret universitet inden for det tekniske og naturvidenskabelige område. Universitetet arbejder inden for fire hovedopgaver: Uddannelse, forskning, forskningsbaseret rådgivning og innovation. Universitetets hovedopgaver er forankret i institutter, i andre universitetsenheder og i datterselskaber.
Universitetets faglige spydspidser ligger inden for de tekniske og naturvidenskabelige områder og med store satsninger inden for en række samfundsrelevante ingeniørdiscipliner, herunder digitalisering, bæredygtig energiteknologi og life science.
Universitetet yder forskningsbaseret rådgivning til danske myndigheder og internationale organisationer. Store dele af det løbende rådgivningsarbejde hviler på et flerårigt aftalegrundlag med en række sektorministerier.
DTU udnytter slagkraften i samarbejdet på tværs af forskningsfelter og organisatoriske enheder til at skabe et innovativt universitet. Dette understøttes blandt andet af forskerparkaktiviteterne gennem datterselskabet DTU Science Park A/S og selskabet PreSeed Ventures A/S, der investerer risikovillig kapital i teknologiske opstartsvirksomheder i etableringsfasen.
Desuden ejer universitetet følgende enheder: Bioneer A/S (GTS-institut) der er en bioteknologisk forsknings- og konsulentvirksomhed inden for biomedicin og bioteknologi. DFM A/S – Dansk Fundamental Metrologi (GTS-institut) der er et nationalt måleteknisk institut og som udbyder måleteknisk ekspertise bl.a. i form af kalibrering, referencematerialer og rådgivning. Dianova A/S der er innovations- og kommercialiseringspartner for forskere og virksomheder inden for life science-området (pt. hvilende).
Lektor Jakob Blæsbjerg Hoof fra DTU Bioengineering udforsker svampenes mange funktioner bl.a. deres evne til at støtte planters produktion af bioaktive stoffer. Med adgang til DTU’s omfattende svampesamling undersøger han både nyttige og skadelige arter. Hans mission er at dele fascinationen med de studerende og skabe grobund for en fremtidig kandidatuddannelse med svampe i centrum
Ledelsesberetning Årets faglige resultater
Særlige strategiske og organisatoriske resultater DTU har i 2025 leveret stærke resultater på tværs af universitetets kerneområder. Året bød på flere første spadestik til ny kritisk forskningsinfrastruktur, markant videreudvikling af innovationsaktiviteter og topplaceringer på relevante rankings. DTU blev for tredje år i træk kåret som Europas bedste tekniske universitet på EngiRank og er blandt de mest attraktive ingeniørarbejdspladser i Danmark. Samtidig viser målinger et højt niveau af studietilfredshed, og søgningen til DTU’s uddannelser nåede et historisk højdepunkt. Desværre måtte DTU give afslag til knap 2.500 kvalificerede ansøgere, som følge af aftalerne om sektordimensionering, udflytning og loft på optaget af internationale studerende.
En evaluering af DTU´s innovationsøkosystem fremhævede universitetets internationalt konkurrencedygtige styrkeposition. Bl.a. samarbejdet med erhvervslivet, uddannelse i innovation og iværksætteri samt et modent system, der understøtter startups i de tidlige udviklingsfaser blev fremhævet. I 2025 blev DTU’s innovationssucces taget til et nyt niveau med skabelsen af DTU SkyFactory, hvor startups kan udvikle sig og bidrage til at styrke Europas konkurrenceevne. Målet er at hver tiende DTU-startup skal have skaleringspotentiale - og støtte til at forløse det. Som en del af det danske EU-formandskab var DTU medvært for innovationskonferencen ASCEND, hvor Europas udfordringer blev tydelig: behov for stærk forskning og talentmasse, og begrænset evne til at skalere deep techløsninger på tværs af kontinentet.
I forbindelse med Danmarks EU-formandskab afholdte DTU konferencen ASCEND i samarbejde med Uddannelses- og Forskningsministeriet, European Innovation Council og Novo Nordisk Fonden og samlede ledere og eksperter fra hele Europa. Formålet var at styrke Europas evne til at skalere deep tech og omsætte banebrydende forskning til globale vækstvirksomheder.
Konferencen satte fokus på EU’s nye initiativer, der skal gøre Europa til et attraktivt sted for iværksættere, talenter og investorer.

DTU’s brede samarbejder med erhvervslivet – fra forskningspartnerskaber til efteruddannelse og studenterprojekter – afspejles i en historisk placering som nummer tre i Danmark på patentsøgninger, kun overgået af Vestas og Novozymes. Det understreger universitetets innovationskraft, selvom patenter ikke er målet i sig selv, men et middel til at realisere potentialet i forskningen. Året bød på en flot stigning i ansøgninger til uddannelser på DTU, bl.a. havde rekordmange kvote 1-ansøgere med en DTU-uddannelse som førsteprioritet. Universitetet har samtidig styrket sin tilstedeværelse i hele landet, og nye studerende har kunnet se frem til at deltage i studieaktiviteter både på Residential Colleges i Skive, Rødbyhavn og på Bornholm, ofte i tæt samarbejde med lokale virksomheder.
2025 bød desuden på store investeringer i forskningsinfrastruktur. DTU Nanolab udvides med et 700 m² renrum til næste generation af nanofabrikation, centralt for Europas rolle i kvantekapløbet. En ny forskningsbygning til DTU Space er under opførsel og vil styrke arbejdet med teknologier, der udforsker jorden og rummet. Derudover er større byggeprojekter som NNF Cellerator, Origo, Bygning 226 og en ny serverpark i gang. Det er nu fem år siden NASA´s Perseverance-rover landede på den røde jord på Mars, med et avanceret kamerasystem til køretøjet, udviklet på DTU Space. Forskerne har nu identificeret kemiske forbindelser, som man typisk forbinder med biologisk liv, hvilket er et stort skridt mod at afklare, om der har været liv på Mars.
DTU styrkede også Danmarks digitale og grønne omstilling. For at styrke datasuveræniteten i Europa åbnede DTU’s nationale supercomputer Computerome i 2025 for bredere adgang. Tidligere har Computerome været målrettet universitetsmiljøer og sundhedsforskning med mange personfølsomme data, men nu kan alt fra offentlige institutioner til private virksomheder benytte supercomputerens kraftige regnekraft, som i høj grad anvendes til eksempelvis AI-modeller samt en lang række andre formål. Samtidig er forskningsinitiativet BRIGHT, Biotechnology Research Institute for the Green Transition, åbnet. En bevilling fra Novo Nordisk Fonden på ca. 1 mia. kr. over syv år sikrer, at det missionsdrevne forskningsmiljø med omkring 300 ansatte kan fortsætte arbejdet med at udvikle biobaserede løsninger til den grønne omstilling, inden for bæredygtige materialer, mikrobielle fødevarer og mikroorganismer til klimaneutralt landbrug.
2.500
DTU måtte i 2025 give afslag til knap 2.500 kvalificerede ansøgere. Heraf 1.200 førsteprioritetsansøgere.
Forskning
DTU udførte i 2025 eksternt finansierede forskningsaktiviteter inkl. anlægsdonationer for i alt 2.670 mio. kr. Det udgør en stigning på 12 pct. ift. 2024. Midlerne er fordelt på 964 mio. kr. fra danske offentlige kilder, 1.017 mio. kr. fra danske private kilder, 401 mio. kr. fra EU, 195 mio. kr. fra øvrige udenlandske kilder og 93 mio. kr. fra anlægsdonationer.
DTU havde 1.995 aktive projekter med erhvervslivet i 2025, som havde et økonomisk omfang på 1.212 mio. kr. Udviklingen afspejler en stigning i det økonomiske omfang i samarbejdet med erhvervslivet på 6 pct. ift. 2024. DTU’s hjemtag fra EU Horizon Europe 2021-2025 har rundet 1,8 mia. kr. og placerer DTU i top-4 blandt de europæiske universiteter.
Publikationer og internationale ranglister I 2025 udgav DTU 3.667 artikler i Web of Sciencetidsskrifter, hvilket er et fald på 1 pct. i forhold til 2024. I en sammenligning med Nordic Five Techog EuroTech-universiteterne ligger DTU som det tredje bedste blandt de ti universiteter på det emnenormaliserede citationsimpact og som det andet bedste på andelen af publikationer, som tilhører verdens 10 pct. mest citerede. Andelen af videnskabelige publikationer med internationale medforfattere var 73 pct. i 2025.
I 2025 fik DTU for tredje år i træk førstepladsen på ranglisten, EngiRank, der baseret på anerkendte datakilder, vurderer kvaliteten af tekniske universiteter i Europa. Placeringen afspejler DTU’s strategiske fokus på at tilbyde ingeniøruddannelser i topkvalitet, levere excellent forskning og være erhvervslivets foretrukne partner.
På Leidens rangliste for erhvervssamarbejde (sampublikationer med virksomheder) er DTU nr. 25 i verden, nr. 7 i Europa og nr. 2 i Norden. På QS World University Rankings, som vurderer forskning, uddannelse, omdømme og internationalt
1.212
DTU havde 1.995 aktive projekter med erhvervslivet i 2025, som havde et økonomisk omfang på 1.212 mio. kr.
engagement, er DTU nr. 107 i verden, nr. 42 i Europa og nr. 5 i Norden. På Times Higher Education World University Rankings, der ligesom QS, er baseret på indikatorer for forskning, uddan nelse, omdømme og internationalt engagement, er DTU nr. 121 i verden, nr. 47 i Europa og nr. 8 i Norden.
Elitebevillinger og -priser Forskere fra DTU har i 2025 modtaget en række elitebevillinger og -priser fra danske offentlige og private fonde.
Fra de offentlige fonde har Danmarks Frie Forskningsfond tildelt tre Sapere Aude DFF-Forskningsleder til yngre forskere fra DTU. Desuden har to yngre forskere modtaget Eliteforskrejsestipendier. Fra Danmarks Grundforskningsfond har DTU modtaget én DNRF Chair bevilling. Fra det Europæiske Forskningsråd ERC har DTU forskere modtaget to bevillinger.
Fra de private fonde har Novo Nordisk Fonden tildelt to Challenge Programme bevillinger, to Investigator bevillinger, én NNF NERD bevilling samt én RECRUIT bevilling til DTU-forskere. Dygtige DTU-forskere har ligeledes modtaget fire Villum Investigator- og fire Villum Young Investigatorbevillinger fra Villum Fonden. Lundbeckfonden har tildelt to LF Fellows- og to Ascending Investigatorbevillinger til DTU-forskere. Fra Carlsbergfondet har DTU forskere modtaget to Semper Ardens Accelerate- og to Semper Ardens Accomplishbevillinger. Endelig har én DTU-forsker modtaget EliteForskprisen 2025.
Forskningsinfrastruktur
Som eliteuniversitet har DTU fokus på forskningsinfrastruktur og udstyr af høj kvalitet. Der investeres løbende og investeringerne danner grundlag for såvel forskning som uddannelse og innovation. Det Nationale Roadmap for Forskningsinfrastruktur 2025 indeholder fire DTU ledede projekter og seks projekter med DTU-deltagelse. To af disse projekter har fået bevilling i 2025. Det drejer sig henholdsvis om Nuclear Salt Loop Facility-projektet, som har fået bevilling til etablering af et laboratorium, hvor der forskes i drift af saltsmeltereaktorer. Projektet har et budget på i alt 33,3 mio. kr. Det drejer sig om Danish Fusion Infrastructure-projektet, som har fået bevilling til at etablere et unikt testanlæg for forskning i fusionsenergi, der bygges på DTU. Projektet har et samlet budget på 68 mio. kr.
Dana V, nyt arktisgående forskningsskib
DTU indgik i foråret 2025 kontrakt med et spansk skibsværft for byggeriet af Dana V, Danmarks nye arktisgående forskningsskib. Skibet bliver en fleksibel og moderne forskningsplatform til marine og maritime opgaver i bl.a. europæiske og arktiske farvande og leveres fra værftet i efteråret 2027.
PFAS-forskningscenter
PFAS-forskningscentret blev oprettet i 2025 på baggrund af midler fra forskningsreserven for 2024, tildelt efter initiativ fra DTU. Centret er et samarbejde mellem DTU, Københavns Universitet, Syddansk Universitet og Aarhus Universitet og skal med nye faciliteter samle og udvikle viden om PFAS’ effekter i samfundet.

DTU-studerende har udviklet en proteinrig frikadelle baseret på blåmuslinger, hvilket er en af de mest bæredygtige kilder til animalsk protein. Med deres produkt Eat Myt vil de gøre muslinger til en naturlig del af dansk hverdagsmad. Efter succes på Green Challenge og stor interesse fra forbrugere arbejder holdet nu på at teste produktet i restauranter og forberede fremtidig masseproduktion.
Under køllægningen af Danmarks nye forskningsskib Dana V blev en mønt lagt under skibets bund som et maritimt ritual, der skal bringe held til både skib og besætning. Dana V er et avanceret oceangående forskningsskib som bl.a. skal styrke arbejdet med havforskning i Rigsfællesskabet.
Uddannelse
Optag
DTU optog i 2025 i alt 763 diplomingeniørstuderende og 1.260 bachelorstuderende i teknisk videnskab, hvilket samlet set er et fald på 6 pct. i forhold til 2024. Faldet skyldes de politisk fastsatte dimensioneringer af DTU’s uddannelser.
På kandidatniveau optog DTU 2.843 studerende mod 2.736 året før, hvilket svarer til en stigning på 4 pct. Stigningen skyldes et højere optag af internationale studerende (+11 pct.), mens optaget af danske studerende faldt med 2 pct.
Dimittender
I alt 2.940 studerende dimitterede fra DTU i 2025, heraf 2.232 civilingeniører og 708 diplomingeniører. Det samlede antal dimittender steg med knap 4 pct. ift. 2024. Udviklingen dækker over en 7 pct. stigning blandt civilingeniørerne og et 6 pct. fald blandt diplomingeniørerne. Udviklingen afspejler forskydninger i optaget i forhold til tidligere år.
Uddannelsesudvikling
Implementeringen af det reviderede polytekniske grundlag for civilingeniøruddannelsen fortsatte

i 2025 og bliver fulgt tæt gennem systematiske evalueringer med deltagelse af både studerende og undervisere. Det styrkede fundament skal sikre et sammenhængende uddannelsesforløb med tydelig progression i de faglige kompetencer.
På diplomingeniøruddannelsen er det obligatoriske introkursus i matematik og de nye matematikkurser på 1. og 2. semester fuldt implementeret. Samtidig er udviklingen af et polyteknisk grundlag for diplomingeniøruddannelsen igangsat som led i en bredere omlægning af uddannelsens struktur. Det polytekniske grundlag omfatter bl.a. naturvidenskab, energi, data og digitalisering, der løbende vil blive indarbejdet i nye diplomingeniøruddannelser og ved revision af eksisterende.
AI i undervisning og eksamen
Generativ AI fylder stadig mere i uddannelsesudviklingen, og fremkomsten af nye værktøjer, herunder værktøjer uden internetadgang, udfordrer traditionelle eksamensformer. DTU arbejder for, at AI teknologier i videst muligt omfang skal kunne bruges i både undervisning og til eksamen. Indsatsen handler grundlæggende om, hvilke kompetencer fremtidens ingeniører skal have, og hvordan DTU bedst afprøver dem, samtidig med at uddannelsernes høje faglige kvalitetsniveau fastholdes.
DTU i hele Danmark
DTU har i 2025 yderligere styrket sin tilstedeværelse i hele landet. Ud over de studerende i Lyngby og Ballerup, er der nu også kandidat- og diplomingeniørstuderende i Hirtshals, Kalundborg og Frederikshavn. Derudover har mere end 160 studerende deltaget i studieaktiviteter på Residential Colleges i Skive, Rødbyhavn og på Bornholm, ofte i tæt samarbejde med lokale virksomheder.
DTU har i 2025 fået godkendt en ny diplomingeniøruddannelse i Industriel Teknologi på Risø Campus med første optag i september 2026. Uddannelsen er den første af flere, der planlægges på Risø Campus.

Området skal udvikles til et internationalt hotspot inden for energi og bioteknologi. Her skal forskere, studerende og virksomheder mødes for at udvikle, teste og markedsprøve fremtidens grønne løsninger.
Trivsel og karriere
Studiestarten, som blev omlagt i 2024, opnåede i 2025 en rekordhøj deltagelse på 91,3 pct. Evalueringen, som er gennemført via den obligatoriske studiestartsprøve med 99,5 pct. svarprocent, viser, at studiestarten styrker trivsel, sammenhængskraft og mindsker frafald. 87 pct. af de studerende angiver at have haft en god start, både fagligt og socialt, og 98 pct. oplever støtte til at etablere et indledende netværk. Studiemiljørapporten 2024 bekræfter den generelt høje tilfredshed med DTU’s faglige, sociale, psykiske, fysiske og digitale studiemiljø og peger samtidig på områder, der forbedres frem mod næste rapport i 2026.
DTU styrkede også overgangen fra studie til karriere.
DTU Career Week havde rekordstor deltagelse, og projektet Best practice for starting a career in
Denmark førte til nye initiativer og partnerskaber, der understøtter fastholdelse af internationale dimittender. Talent Partner programmet blev videreført, og DTU Industrial Partnerships Summit samlede studerende, institutter og industri om fremtidens kompetencebehov. DTU’s internationale dimittender opnåede fortsat meget høj beskæftigelse, hvilket i 2025 udløste en bonus på 13,1 mio. kr. – den højeste blandt danske institutioner.
DTU Student’s Culture Hub
Culture Hub understøtter arbejdet med at skabe et inkluderende campusmiljø og med at modvirke ensomhed. Student’s Culture Hub, der spiller en central rolle i Studiestart og Introduction Week, gennemførte i 2025 15 arrangementer med ca. 2.000 deltagere og etablerede fem faste communities. Hub’en er et vigtigt element i DTU´s samlede indsats for et stærkt studiemiljø og gode trivselstilbud.
Hvert år inviterer DTU potentielle studerende på besøg til Åbent Hus for at høre om de udbudte ingeniøruddannelser.

Studenterdrevne projekter
DTU markerede i 2025 15 års jubilæet for GRØN DYST, hvor 120 studerende præsenterede innovative og bæredygtige løsninger på lokale og globale udfordringer. Under Blue Dot konceptet deltog otte projekter med ca. 100 studerende. Projekterne handlede om at udvikle innovative og banebrydende teknologier, og knap 100 studerende deltog på Roskilde Festival med 24 projekter. Projekterne giver praktisk erfaring og skaber dynamiske læringsmiljøer på tværs af fagligheder, hvor idéer bliver til handling.
Nyt studieinformationssystem (Nyt SIS)
DTU har fortsat værtsrollen for det fælles Nyt SIS program på vegne af syv universiteter. DTU driver samtidig det lokale Nyt SIS program, der dels omfatter implementering af det
fælles standard-system, dels en række lokale forandringsprocesser.
Internationalt udsyn
I 2025 var 614 DTU studerende på udlandsophold, og 859 udvekslingsstuderende kom til DTU. Faldet i udgående mobilitet skyldes især færre selvarrangerede ophold. DTU’s deltagelse i EuroTeQ Engineering University fortsætter som et centralt samarbejde mellem førende tekniske universiteter og business schools i Europa. Samarbejdet prioriterer semestermobilitet på tværs af partneruniversiteterne og giver bl.a. de studerende adgang til et fælles kursuskatalog, virtuel mobilitet, deltagelse i det projektbaserede program ”EuroTeQ Collider”.
Hvert år i september byder DTU nye kandidatstuderende velkommen med introduktionslege og andre sociale aktiviteter. De nye studerende får tildelt en buddy, som står for at planlægge og gennemføre studiestarten på kandidatuddannelserne.


DTU Startup Day fejrer universitetets stærke innovationskultur og bringer forskere, iværksættere, investorer og mentorer sammen. Dagen er dedikeret til at fremme nye idéer, netværk og teknologier, der kan skabe værdi for samfundet. I DTU Skylab summer auditoriet af pitch-præsentationer, faglige debatter og nye samarbejdsmuligheder.

DTU-studerende deltog i årets farverige Prideparade for at fejre retten til mangfoldighed og et inkluderende studiemiljø. DTU arbejder målrettet for et universitet, hvor alle føler sig værdsat og mødt med respekt uanset baggrund, køn eller identitet. Deltagelsen blev arrangeret af DTU’s studenterforening PF.
Øjebliksbillede af studiemiljøet på Lyngby Campus bygning 324.
Innovation
DTU’s økosystem for innovation
DTU Startup Day er den årlige markering af DTU’s stærke økosystem for innovation og samlede endnu engang entreprenører, industri, investorer og beslutningstagere til faglige drøftelser, paneldebatter og præsentationer af nye tech iværksættere og prototyper.
Som del af det danske EU-formandskab havde
DTU’s økosystem for innovation ansvaret for innovationskonferencen ASCEND, hvor både preevent og hovedkonference lancerede en rapport med anbefalinger og bød på internationale oplæg og netværksaktiviteter.
Innovationshubben DTU Skylab er medstifter af det toneangivende europæiske netværk Rise Europe, der samler førende start-up og innovationsmiljøer. Det årlige summit blev afholdt på DTU med fokus på Europas globale innovationsposition. I 2025 havde DTU Skylab 204.798 besøgende, gennemførte 83 events og samarbejdede med 41 eksterne virksomheder og organisationer. 968 unikke brugere benyttede værksteder og laboratorier, og 432 startup-projekter modtog coaching og support. DTU start-up-projekter modtog desuden over 30 mio. kr. i soft funding til videreudvikling af teknologi og forretningsidéer.
Kommercialisering og startups
DTU blev i 2025 kåret som Danmarks tredje mest patentsøgende virksomhed. Året bød på 99 anmeldelser af kommercialisérbare opfindelser og tre softwareopfindelser, hvilket hævede den samlede IPR-portefølje til 659 ved årets udgang.
I 2025 indgik DTU 39 nye salgs-, licens- og optionsaftaler, der omfattede 56 opfindelser og tre softwarestykker. Heraf gik 18 til DTU start-ups, 13 til etablerede virksomheder, seks til virksomheder, hvor IP og forhandlinger udsprang af et samarbejde,
opfindelser er kommercialiseret
samt to til industristart-ups, etableret for at modtage DTU-IP. Indtægterne fra IPR-porteføljen endte på 16,5 mio. kr.
DTU bidrog også i 2025 med et markant antal nye teknologiske virksomheder. Der blev etableret 117 nye start-ups baseret på DTU-viden: fordelt på 82 studenterstart-ups og 35 medarbejderstart-ups.
Samarbejde med omverden
DTU har et tæt og omfattende samarbejde med erhvervslivet med 1.463 aktive forsknings- og innovationsprojekter. Samarbejdet omfatter bl.a. tværdisciplinære partnerskaber med virksomheder som Novo Nordisk, Mærsk, IFF, AGC Biologics og Andel. I DTU’s Talent Partner-program indgår 25 virksomheder.
Teknisk Universitetshospital (TUH) blev i 2025 videreudviklet med en bred mobilisering af klinisk personale og DTU-forskere. Der blev etableret flere delestillinger, og i løbet af året blev 19 adjunkter, lektorer og professorer ansat i TUH. Samtidig udvides TUH fra hospitalerne i Region Hovedstaden til nu også at omfatte alle hospitaler i den nye Region Øst. En bred kreds bestående af 17 partnere, heriblandt DTU, står bag en ny forening Innovation District Copenhagen, offentliggjort i januar 2026.
Foreningen skal realisere visioner for hovedstadens koncentration af forskning og talent og udvikle en internationalt orienteret test- og udviklingszone.
Forskningsbaseret rådgivning
DTU’s rådgivning er primært forankret i strategiske rammeaftaler med danske myndigheder: Ministeriet for Fødevarer, Landbrug og Fiskeri, Miljø- og Ligestillingsministeriet, Transportministeriet, Klima-, Energi- og Forsyningsministeriet, Sundhedsstyrelsen, Miljøstyrelsen og Fødevarestyrelsen samt Forsvarets Efterretningstjeneste. Kontraktsummen fra rammeaftalerne udgjorde i 2025 ca. 255 mio. kr.
Flere end 100 DTU-forskere rådgiver internationalt, på EU- eller globalt niveau, fordelt på en række faglige områder. I 2025 etablerede DTU en intern mentorordning for at understøtte kompetenceudvikling og impact af DTU’s internationale rådgivning.
Opbygning af strategiske forskningsmiljøer På forskningsreserven for 2025 var der, ligesom de to foregående år, afsat midler til fortsat opbygning af varige forskningsmiljøer på strategisk prioriterede områder inden for den forskningsbaserede rådgivning. DTU anvendte i 2025 midlerne som tilskud til de myndighedsbetjenende institutter, der siden fusionen i 2007 har været underlagt
3.691
I 2025 udgav DTU 3.691 artikler i Web of Science-tidsskrifter
Nr. 1
DTU opnåede i 2025 igen en flot placering på EngiRanks rangliste, da universitetet blev placeret som nummer 1 i EU for tredje år i træk

årlige 2 pct.-besparelser. Midlerne bidrog i 2025 til forskning og kapacitetsopbygning inden for en række rådgivningsområder og var medvirkende til at afbøde besparelsernes negative konsekvenser for de myndighedsbetjenende fagmiljøer.
Komplekse udfordringer kræver tværgående løsninger
DTU har igennem årene etableret en række centre, der samler og synliggør universitetets kompetencer på tværs af fagområder og i tæt samarbejde med erhvervsliv, brancheorganisationer og myndigheder. Gennem disse centre adresserer
DTU centrale og komplekse samfundsudfordringer
- bl.a. inden for søfart, forsvar og Arktis, samt det kvanteteknologiske og det nukleare område.
Skjoldet, stiftet af Natasha Hougaard og Magnus Stjernborg Koch, tildeltes Årets studenter startup ved DTU Årsfest. Deres produkt er udviklet hos DTU Skylab og med deres værktøj hjælper de tusindvis af brugere med at undgå svindelsider og færdes mere sikkert på nettet. Prisen blev overrakt af koncerndirektør Marianne Thellersen og ledsages af 25.000 kr. til videre udvikling.
Bygning 324 er en af DTU’s nyere bygninger og er designet af arkitekt Thomas Nørgaard. Den er skabt som et lyst og åbent læringsmiljø med specialdesignede studiepladser. Bygningen er udstyret med solceller, regnvandsopsamling og naturlige ventilationsprincipper, som understøtter dens 0-energikoncept og sikrer et stabilt indeklima.
Campusudvikling
Eksperimentelle faciliteter og læringsmiljøer i verdensklasse
Campusudviklingen følger universitetets overordnede strategi om at udvikle eksperimentelle faciliteter og læringsmiljøer i verdensklasse, og campusudviklingen prioriterer smukke og funktionelle campusser med fokus på bæredygtighed. Universitetet råder over campusser i Lyngby, Ballerup og Risø samt en række særlige faciliteter andre steder i Danmark, som vindmølletestcentre i Østerild og Høvsøre, fiskeriforskningsfaciliteter i Hirtshals, Nykøbing Mors og Silkeborg, samt undervisningsfaciliteter i Sisimiut i Grønland. Som led i ”DTU i Danmark”, er DTU yderligere til stede ved Kalundborg, Rødbyhavn, Skive og Rønne.
Ved DTU Risø Campus arbejdes der fortsat med en udviklingsplan for arealet øst for Frederiksborgvej med henblik på bedst mulig udnyttelse af området til undervisning og forskning. Sideløbende hertil arbejdes der fortsat i regi af ”Risø Gateway” om en fremtidig vision om Risø Erhvervspark med fokus på forskning, uddannelse og erhverv indenfor bæredygtig energi.

DTU Lyngby Campus har arbejdet med en ny lokalplan for arealet langs motorvejen og det eksisterende campus. Lokalplanen tilgodeser udviklingsmuligheder for et moderne universitets fremtidige behov til forskning og uddannelse. Som led i et godt samarbejde med Lyngby-Taarbæk Kommune, arbejdet med borgerinddragelse og naboer har DTU inviteret til Åbent Hus, hvor borgerne får mulighed for at besøge og opleve forskning i praksis. Der er gennemført en række arrangementer med stor succes. På DTU Ballerup Campus er der udarbejdet en helhedsplan som supplement til Strategisk Campusplan.
Større byggeprojekter
Inden for rammerne af den overordnede campusplan kan nævnes flere markante byggerier i 2025, som enten er i gang eller afsluttet:
• DTU i Danmark – Etablering af lejemål til DTU på Campus Kalundborg i gang, samt indledende tiltag til etablering af uddannelser på Risø i gang
• Nybyggeri på Lyngby Campus til udvidelse af DTU Nanolab
• Nybyggeri på Lyngby Campus til DTU Space
• Novo Nordisk Fondens Cellerator-facilitet til stamcelleforskning er under opførelse
• Igangsat projektering af Origo, ny eventhub og mødested
• Igangsat projektering af bygning 226, en bygning til flere brugere med fokus på læringsog kontormiljø
• Igangsat projektering af ny serverpark, bl.a. i samarbejde med European Spallation Source (ESS) i Lund
Klima- og miljøpåvirkning
DTU bestræber sig på at skabe og udvikle fysiske rammer på campusområderne med løsninger, der bidrager til at mindske negativ påvirkning af klima og miljø.
Konkrete eksempler på tiltag er etablering af vedvarende energiløsninger som solcelleanlæg og varmepumper på campusserne. Derudover opsamler DTU vand til brug på udendørs arealer og genbruger inventar og IT-udstyr.
DTU anvender fortsat DGNB- certificering som ramme for arbejdet med byggeri, både i nye projekter, renoveringer og i campusplanlægningen. For at styrke biodiversiteten på campus beplanter DTU med hjemmehørende arter ved nye landskabsprojekter. Direktionen har bevilliget midler til et
NØGLETAL 2025
Indikator
Energiforbrug pr. studerende og ansat
CO2-udledning pr. studerende og fuldtidsansat*
CO2-udledning pr. fuldtidsansat fra flyrejser
Vandforbrug
forskningsprojekt, hvor Center for Absolut Bæredygtighed i samarbejde med Campus Service udvikler indikatorer og etablerer en 2025 baseline for henholdsvis CO2, ressourcer, forurening og biodiversitet. Rapporten forventes ultimo 2026.
Nøgletal præsenteres i tabellen herunder og yderligere data præsenteres i Grønt regnskab på side 72.
2025 Status
20,4 % reduktion i forhold til baseline (2017-19)
78,8 % i reduktion forhold til baseline (2017-19)
40,5 % i reduktion forhold til baseline (2019)
20.5 % reduktion i forhold til baseline (2017-19)
Personale
Universitetets samlede personalestab steg med 279 årsværk til 6.574 årsværk i 2025. Stigningen i antal årsværk skyldes primært en stigning på 175 årsværk på institutterne og flere årsværk til løsning af opgaver for universiteternes fællesskaber. For yderligere information om universitetets personaletal henvises der til Personale og arbejdsmiljø på side 84.
Diversitet, lighed og inklusion
DTU tror på, at diversitet, lighed og inklusion er en forudsætning for at finde banebrydende løsninger på samfundets udfordringer. Fokus er kontinuerligt på diversitet ved at have en medarbejdersammensætning, der er repræsentativ for det samfund, DTU er til gavn for, hvilket betyder, at vi har haft særligt fokus på at ansætte flere kvindelige professorer, som også kan være rollemodeller for studerende og yngre forskere. Mhp. at fremme lighed har DTU i 2025 gennemført initiativer, der understøtter lige adgang i rekrutteringer, fjerner bias i lønforhandlinger, implementerer Coalition for Advancing Research Assessmentprincipperne ift. meritering af forskere og forskningen samt fortsat understøttelse af studerende med særlige behov gennem SPS.
Dertil stræber DTU efter at have en inkluderende kultur, hvor barren for det nysgerrige spørgsmål bliver sænket. I 2025 har vi haft fokus på at understøtte, at denne kultur kan komme ud på hele universitetet gennem etablering af et DEI Community samt fortsat fokus på dialog om trivsel.
Endeligt har fokus været på repræsentation i forskningen og tilrettelæggelse af forskningsprocessen mhp. at understøtte den sociale bæredygtighed.
Forskeruddannelse
DTU optog i alt 401 ph.d.-studerende i 2025. Ud af det samlede ph.d.-optag er 36 erhvervs-ph.d.-studerende, mens 241 er internationale ph.d.-studerende. I 2025 tildelte DTU 465 ph.d.-grader. Den samlede bestand pr. 31. december 2025 er 1.616 ph.d.-studerende.
465
ph.d.-grader er tildelt i 2025

Branding
Når DTU deler viden med borgere, erhvervsliv og politikere, skaber det værdi og understøtter udviklingen af et demokratisk videnssamfund. Med et genkendeligt design, en fælles kommunikationspolitik og en målrettet kommunikationsindsats sætter DTU rammerne for tydelig og tilgængelig videndeling. Forskerne understøttes gennem rådgivning og pressetræning, og DTU´s viden formidles bredt via artikler, videoer, illustrationer, nyheder m.m.
DTU prioriterer sin kommunikationsindsats ud fra en strategisk beslutning om at fokusere på aktuelle, og for universitetet særligt vigtige, temaer – både internt og eksternt. Det betyder, at der hver dag træffes valg om, hvilke indsatser der bedst sikrer, at DTU når flest mulige målgrupper med størst mulig effekt.
I 2025 blev DTU’s kommunikation styrket markant på tværs af kanaler. Der blev etableret 45 nye websites, gennemført over 150 designopgaver og produceret 12 rektortalks på video. Hertil kommer 48 pressemeddelelser, 67 forskningsformidlende artikler, 60 grundfortællinger og 10 presseberedskaber i forbindelse med større DTU-begivenheder. Mere end 50 forskere modtog desuden pressetræning og sparring.
DTU’s budskaber blev udbredt bredt via sociale medier. Direktionen nåede mere end 2 mio. personer gennem 280 opslag på LinkedIn, hvor 35.700 følger deres profiler. På DTU’s corporate kanaler (LinkedIn, Facebook og Instagram) blev der publiceret 747 opslag med i alt 7,9 mio. visninger. Derudover blev der produceret 23 interne nyhedsbreve på dansk og engelsk. Nyhedsbrevene understøtter medarbejdernes indsigt i strategiske beslutninger og driften.
Uddannelsesrekruttering Kommunikation til potentielle studerende er en væsentlig del af DTU’s branding, mangfoldighedsdagsorden og ambition om at være til gavn for alle. I 2025 udviklede DTU en ny fælles
232.000
personer følger DTU på LinkedIn
44.000
personer følger DTU på Facebook
25.900
personer følger DTU på Instagram
uddannelsesfortælling og kampagnekoncept til alle uddannelserne. Det sikrer én sammenhængende fortælling og ét genkendeligt udtryk i alt kampagneog informationsmateriale – og dermed en større gennemslagskraft i rekrutteringen fra bachelor til livslang læring.
Ud over kampagner gennemfører DTU en række aktiviteter for potentielle studerende: Åbent Hus på Lyngby Campus med ca. 2.400 gæster, det landsdækkende online Åbent Hus og Studieinfo DTU med 1.389 besøg samt studiepraktik for 300 gymnasieelever. Dertil kommer målrettede indsatser i hele landet – samt i Grønland og på Færøerne.
High-Level Visits
I 2025 afholdt DTU 70 High Level Visits, herunder 11 High Level Events bl.a. relateret til EU formandskabet og indvielser af bygninger eller centre. De omfattede et besøg af Kongehuset, 19 fra ministre og EU-kommissærer, 38 fra ambassadører og 7 fra politikere.
Akademiske højtideligheder Årsfesten blev afviklet som både fysisk og livestreamet event. Der deltog knapt 4.000 personer, herunder ca. 400 af rektors gæster med ledsagere.

Der blev afholdt seks dimittendreceptioner med 1.102 dimittender, en ph.d.-reception med 225 dimittender, en Ørsted Lecture, en professormiddag, en Uniform på jobbet-dag, fire rektors nytårskure, heraf én virtuel og en julekoncert.
Outreach
DTU deltog som sædvanlig på Folkemødet på Bornholm, hvor universitetet bidrog til den demokratiske samtale i mere end 28 debatter, møder og netværks arrangementer. På Naturmødet i Hirtshals kom ca. 2.300 gæster forbi DTU-teltet, hvor de kunne opleve oplæg, aktiviteter og en interaktiv udstilling. Der var rige muligheder for aktiv deltagelse i videnskabelige temaer med fokus på børns engagement i STEM.
SommerScience samlede 181 børn og unge i alderen 6-18 år med aktiviteter på hhv. Lyngby Campus, Nordsøens Oceanarium og Den Blå Planet i samarbejde med institutter og eksterne partnere.
Alumner
DTU’s alumnenetværk, "Alumner og venner", har over 46.000 medlemmer. Seks årlige nyhedsbreve på dansk og engelsk samt andre udsendelser har høje åbningsrater. Mange alumner bidrager årligt til DTU’s udvikling som advisory board-medlemmer, mentorer, gæstetalere, oplægsholdere, vigtige bindeled til samarbejdspartnere mv.
DTU 200 år i 2029
Forberedelser til fejring af DTU’s 200-års jubilæum blev igangsat i sensommeren med aktivering af styregruppe samt fire spor med fokus på en bred involvering af hele DTU.
Mere end
2.000
nye medlemmer af universitetets alumnenetværk
Femern Bælt-projektet set fra oven. DTUstuderende får mulighed for at arbejde tæt på opførelsen af verdens længste sænketunnel og opnå indsigt i et af Europas største og mest komplekse byggeprojekter.

Årets økonomiske
resultat
DTU havde i 2025 et positivt resultat på 8 mio. kr., hvilket er 4 mio. kr. over det budgetterede.
Driftsindtægter i alt udgør 6.749 mio. kr., hvilket er 31 mio. kr. lavere end budgettet. Indtægter fra Statstilskud er 45 mio. kr. højere end budgettet som følge af øget antal studenterårsværk, beskæftigelsesbonus for engelsksprogede dimittender, decentrale grundtilskud og fremgang i Adgangskursus. Salg af varer og tjenesteydelser samt Andre indtægter er 71 mio. kr. lavere end budgettet primært som følge af forsinkelse i udmøntning af kvantebevilling via DeiC. Denne har modsatrettet effekt på relaterede driftsomkostninger og er dermed uden resultateffekt.
Driftsomkostninger i alt inklusive afskrivninger udgør 6.610 mio. kr., hvilket er 12 mio. kr. højere end budgettet. Personaleomkostninger er 147 mio. kr. højere end budgettet, heraf udgør tilskudsfinansierede aktiviteter 70 mio. kr. Stigningen skyldes primært et stigende antal årsværk på overvejende VIP-stillinger. Afskrivningerne er 46 mio. kr. højere end budgettet som følge af en regnskabsmæssig ændring vedrørende gebyromkostninger til patenter med en effekt på 27 mio. kr. samt forskydning af anlægsudgifter mellem regnskabsår. Øvrige driftsomkostninger er 205 mio. kr. lavere end budgettet som følge af øget omkostningsfokus i sammenhæng med højere lønomkostninger, lavere energi- og forsyningsomkostninger, lavere ejendomsskat samt ovenstående forsinkede udmøntning af kvantebevilling.
Årets Finansielle nettoomkostninger er 132 mio. kr., hvilket er 23 mio. kr. lavere end budgettet. Det skyldes primært positivt afkast på værdipapirer og højere likvide beholdninger. Sidstnævnte skyldes dels højere likviditet ved årets start og en positiv udvikling i likviditet fra drift, samt at realiserede anlægsinvesteringer er lavere end budgetteret, hvilket også bevirker, at et budgetteret lån ikke er optaget i 2025.
Driftsindtægter er i alt 198 mio. kr. højere end i 2024. Indtægter fra Statstilskud er 138 mio. kr. højere som følge af pristalsregulering, øget antal studenterårsværk, beskæftigelsesbonus for engelsksprogede dimittender, decentrale grundtilskud samt fremgang i Adgangskursus. Indtægter fra Øvrige tilskud er 263 mio. kr. højere som følge af øget aktivitet. Salg af varer og tjenesteydelser er 202 mio. kr. lavere end i 2024. Dette skyldes primært, at der fra 2025 registreres udlæg vedrørende administrative fællesskaber i universitetsregi på en balancekonto i overensstemmelse med Uddannelses- og Forskningsstyrelsens konterings- og fordelingsvejledning.
Driftsomkostninger i alt er 166 mio. kr. højere end i 2024. Personaleomkostninger er 278 mio. kr. højere som følge af dels stigende aktivitet på tilskudsfinansierede aktiviteter, overenskomstmæssige lønstigninger og et stigende antal årsværk på overvejende VIP-stillinger. Afskrivningerne er 34 mio. kr. højere end 2024 som følge af en regnskabsmæssig ændring vedrørende gebyromkostninger til patenter samt forskydning af ibrugtagning af større bygge- og anlægsprojekter. Øvrige driftsomkostninger er 152 mio. kr. lavere end 2024 som følge af et generelt øget omkostningsfokus i 2025 og ovenstående regnskabsmæssige ændring af administrative fællesskaber.
Årets Finansielle nettoomkostninger er 26 mio. kr. højere i forhold til 2024, hvilket skyldes faldende indlånsrenteniveau samt reduceret afkast af værdipapirer.
Væsentlige ændringer i anlægsaktiver/ bygningsmæssige forhold
Anlægsaktiver i alt udgør 9.805 mio. kr., hvilket er 90 mio. kr. højere end ultimo 2024 og 603 mio. kr. lavere end budgettet som følge af forskydninger i anlægsprojekter.
Begivenheder efter balancedagen
Der er efter ledelsens opfattelse ikke indtruffet begivenheder efter regnskabsårets udløb af betydning for årsrapporten for 2025.
Hoved- og nøgletal
ØKONOMISKE NØGLETAL
Resultatopgørelse
Statstilskud, mio. kr.
Øvrige tilskud, mio. kr.
Salg af varer og tjenesteydelser, mio. kr.
Andre indtægter, mio. kr.
Driftsindtægter i alt, mio. kr.
Personaleomkostninger, mio. kr.
Husleje, mio. kr.
Af- og nedskrivninger
Tab ved salg af bygninger samt nedskrivning på bygninger til salg, mio. kr.
Øvrige driftsomkostninger, mio. kr.
Driftsomkostninger i alt, mio. kr.
Resultat før finansielle poster og ekstraordinære poster, mio. kr.
Årets
Balance
mio. kr.
gældsforpligtelser, mio. kr.
PERSONALE (ÅRSVÆRK)
Studieaktivitet – ordinære uddannelser
med tilskud fra andre ministerier - - - - -
STÅ på ordinære uddannelser i alt
Antal optagne på diplomingeniøruddannelsen
Antal optagne på kandidatuddannelsen
Antal optagne på øvrige ordinære uddannelser -
Antal indskrevne studerende på ordinære uddannelser i
Antal
Antal færdiguddannede kandidater
Antal færdiguddannede fra øvrige ordinære uddannelser
UDDANNELSE – FORTSAT
Studieaktivitet – deltidsuddannelse/åben uddannelse
STÅ, deltidsuddannelse/åben uddannelse, videregående uddannelser
STÅ, deltidsuddannelse/åben uddannelse, ikke-videregående niveau/øvrig uddannelse -
STÅ, deltidsuddannelse/åben uddannelse i alt
Kursusaktivitet – Indtægtsdækket virksomhed
Kursusaktivitet – indtægtsdækket virksomhed, omsætning
Internationalisering Antal
Forskeruddannelse
af samarbejde med erhvervslivet, mio. kr.
FORSKNINGSBASERET RÅDGIVNING
Forskningsbaseret rådgivning til Ministeriet for Fødevarer, Landbrug og Fiskeri, Miljø- og Ligestillingsministeriet og Transportministeriet
Forskningsbaseret rådgivning til Klima-, Energi- og Forsyningsministeriet, Forsvarets Efterretningstjeneste samt Sundhedsstyrelsen, Miljøstyrelsen og Styrelsen for Fødevarer, Landbrug og Fiskeri
Totalt økonomisk omfang af strategiske rammeaftaler med ministerier
BYGNINGER
Bygningsareal i alt (bruttoareal opgjort i m 2)
* Udenlandske studerende jf. definition nøgletal H i Danske Universiteters statistiske beredskab
** På grund af metodologiske ændringer er tallene for 2024 ikke sammenlignelige med de foregående år, hvilket også gælder for 2025
*** FVM: 187,2 mio. kr., MIM: 19,5 mio. kr., TRM: 16,1 mio. kr.
**** KEFM Geodæsi: 15,4 mio. kr., KEFM Vind: 0,8 mio. kr., FE: 8,3 mio. kr., Radioøkologi: 8 mio. kr.
Samlet opgørelse af mål opfyldelse for DTU’s strategiske rammekontrakt 2022-2025
STRATEGISK MÅL 1
DTU skal være et af Europas fem førende tekniske universiteter og anerkendt for sin polytekniske eliteforskning.
DTU skal bedrive excellent forskning inden for en lang række teknologiske forskningsområder. DTU vil fortsat arbejde for at øge hjemtaget af eksterne bevillinger og styrke den internationale gennemslagskraft ved at tiltrække og fastholde førende forskningskapaciteter. Endvidere vil DTU fortsat styrke sine samarbejdsrelationer og stræbe efter nye samskabende partnerskaber om forskning i verdensklasse samt sikre en veludbygget forskningsinfrastruktur med unikke faciliteter.
Institutionens vurdering af det strategiske mål
DTU vurderer samlet set, at der er en tilfredsstillende udvikling i målet.
I kontraktperioden har DTU øget gennemsnittet af antallet af tildelte excellencebevillinger for en rullende 4-årig periode fra 17,3 (baseline) til 26,5 (20222025). DTU har igennem hele kontraktperioden modtaget i alt 106 excellencebevillinger inden for de fonde og opslag, som er anvendt i hele afrapporteringsperioden, herunder Grundforskningsfondens Centers of Excellence, DFF Sapere Aude, Villum Young investigator, Villum investigator, NNFs investigator grants, Carlsbergfondet Young Researchers Fellowships og ERC-bevillinger.
Derudover har DTU øget hjemtaget (indeks 105) fra Horizon Europe i forhold til gennemsnittet af Nordic Five Tech (N5T) og EuroTech-universiteternes hjemtag (indeks 83), hvor baseline (indeks 100) for DTU og Nordic Five Tech / EuroTech er opgjort til hhv. 358,84 mio. kr. og 215,53 mio. kr. for perioden 2018-2020. Gennemsnittet af DTU’s hjemtag for perioden 2023-25 er 375,27 mio. kr., mens hjemtaget for 2025 er på 341,96 mio. kr. Endvidere har universitetet fastholdt høj forskningskvalitet og international gennemslagskraft igennem kontraktperioden, hvor DTU’s emnenormaliserede citationsimpact på 54 pct. ligger over verdensgennemsnittet for perioden 2020-2024, og dermed er DTU solidt placeret over gennemsnittet for N5T- og EuroTechuniversiteterne med 40 pct. DTU’s andel af de 10 pct. mest citerede publikationer ligger på 17,1 pct. for perioden 2020-2024,
mens gennemsnittet for N5T- og EuroTechuniversiteterne er 15,5 pct.
DTU har i kontraktperioden igangsat og gennemført en lang række understøttende aktiviteter og modtaget et stort antal forskningsbevillinger. Eksempelvis etablerede DTU i 2022 bl.a. Center for Auditiv Neurovidenskab, oprettede et kvantecenter, lagde fundamentet til Climate Challenge Take a guess fordoblede sin produktionskapacitet af radioaktive stoffer til behandling af kræft med konstruktionen af en ny cyklotron på DTU Risø campus. Derudover indgik DTU i 2023 bl.a. en strategisk aftale med Rigshospitalet om tættere samarbejde om uddannelse, forskning, innovation og behandling og var en drivende kraft i etableringen Nationalt Forsvarsteknologisk Center (NFC). Endvidere blev der i 2024 indviet et nyt hybridkraftværk til understøttelse af forskning i el-forsyning fra vedvarende energikilder samt etableret centrene Danish Chips Competence Centre og DTU Nuclear Energy Technology. I den fireårige Nationale Roadmap for Forskningsinfrastruktur 2025, som indeholder 17 projekter, blev fire DTU-ledede faciliteter prioriteret: Nuclear Salt Loop Facility (laboratorium til forskning i saltsmelter), Danish Fusion Infrastructure (unikt testanlæg for forskning i fusionsenerg); Real Time Computing Center (forudsigelse og imødegåelse af nedbrud på strømforsyningen) og Photonic Process Design Kit (udvikling og produktion af avancerede fotoniske chips). Endeligt har DTU både i 2023, 2024 og 2025 opnået status som det bedste tekniske universitet i EU på EngiRank, der vurderer +200 tekniske universiteter fra bl.a. 27 EU-lande, Schweiz, Norge og Storbritannien.
Den 8. oktober bød årets uddannelses- og forskningspolitiske topmøde på vigtige og aktuelle debatter og spændende oplæg fra bl.a. Carlsbergfondets forperson, Majken Schultz. Igen i år deltog også uddannelsesog forskningsminister Christina Egelund, som svarede på spørgsmål fra salen.

STRATEGISK MÅL 2
DTU skal tilbyde Europas bedste ingeniøruddannelse – gennem hele arbejdslivet.
DTU vil udbyde og udvikle ingeniøruddannelser, der matcher samfundets og erhvervslivets behov gennem hele arbejdslivet, og som er på højeste niveau og af højeste kvalitet. DTU’s ingeniøruddannelser skal sikre, at dimittenderne kan mestre den teknologiske udvikling til gavn for mennesker, erhvervsliv og samfund. DTU vil fortsat arbejde med at styrke indsatsen for et mangfoldigt og inkluderende læringsmiljø, hvor bl.a. flere kvinder griber ingeniørfaget.
Institutionens vurdering af det strategiske mål
DTU vurderer samlet set, at der er en tilfredsstillende udvikling i målet.
Danmark Studieundersøgelse viser, at hovedparten af DTU-studerende samlet set vurderer kvaliteten af deres uddannelse som høj (4,3 på en skala fra 1-5), hvilket vurderes meget tilfredsstillende. I kontraktperioden har DTU øget andelen af kvindelige bachelor- og kandidatstuderende på DTU’s diplomingeniør- og civilingeniøruddannelse fra 32 pct. (baseline) til 34 pct. i 2025. Derudover er DTU’s dimittendledighed i 4.-7. kvartal efter endt uddannelse (diplomingeniør- og civilingeniøruddannelsen) faldet fra 7,1 pct. i 2019 (baseline) til 2,5 pct. i 2025, mens tallet for det tekniske hovedområde er faldet fra 10,6 pct. i 2019 (baseline) til 5,5 pct. i 2025 (eksklusiv DTU).
DTU Learn for Life har udbudt 143 kurser i 2025 på videre- og efteruddannelsesområdet, hvilket er en markant stigning på knap 75 kurser i forhold til baseline på 69 udbudte kurser i 2021.
Igennem kontraktperioden har DTU igangsat og gennemført en række understøttende aktiviteter med henblik på at tilbyde uddannelser, der matcher samfundets og erhvervslivets behov gennem hele arbejdslivet. Eksempelvis
blev DTU LearningLab i 2022 etableret som et selvstændigt center for at sikre den faglige forankring ift. kompetenceudvikling, udvikling og forskning. I 2023 blev modellen for civilingeniøruddannelsens struktur og den grundlæggende revision af kurserne i det polytekniske grundlag færdigudviklet og implementeret. I samme år blev DTU’s uddannelsessignatur, der beskriver kendetegn ved DTU’s uddannelser, lanceret. I 2024 oprettede DTU i samarbejde med MARTEC en ny skibsingeniøruddannelse, og i 2025 blev det polytekniske grundlag for DTU’s diplomingeniøruddannelse udviklet. For at sikre ligestilling, mangfoldighed og inklusion, og at flere kvinder rækker ud til ingeniørfaget, er der i kontraktperioden bl.a. udarbejdet nye grundfortællinger om DTU’s uddannelser og mini-portrætter af DTU-kvinder, produceret uddannelsesfilm med kvindelige studerende og afholdt camps for kvindelige gymnasieelever. Endvidere har flere hundrede studerende årligt deltaget i Grøn Dyst, Blue-Dotprojekter og med ingeniørfaglige studieprojekter på Roskilde Festival, og dermed arbejdet med innovative og teknologiske udfordringer og løsninger i tæt interaktion med samfundet. Endeligt har DTU arbejdet målrettet på at styrke hele videre- og efteruddannelsesområdet, herunder organiseringen af centret Learn for Life.
STRATEGISK MÅL 3
DTU’s uddannelser skal være af højeste faglige kvalitet og rammerne for læring og trivsel skal opleves som optimale for de studerende
DTU understøtter et stærkt fagligt og socialt tilhørsforhold og fremmer et levende studiemiljø med høj studieintensitet og engagement. De studerende skal lære forskningens og udviklingsarbejdets arbejdsformer og metoder.
Institutionens vurdering af det strategiske mål
DTU vurderer samlet set, at der er en tilfredsstillende udvikling i målet.
I hele kontraktperioden har DTU fastholdt et højt læringsniveau og tilbudt de studerende 20-24 timers undervisning om ugen. I 2025 blev 99,8 pct. af den planlagte undervisning gennemført, men 97,4 pct. af undervisningen blev udført af fastansatte forskere og undervisere. Derudover har de studerendes egen vurdering af deres tidsforbrug på studiet igennem kontraktperioden ligget på et højt niveau, og i 2025 er tidsforbruget opgjort til 42 timer, hvilket er en stigning på 2 timer i forhold til baseline på 40 timer. Endvidere er de studerendes vurdering af, hvorvidt de føler sig tilpas på deres uddannelse, steget fra 4,0 i 2020 (baseline) til 4,2 i 2025 på en skala fra 1-5. Endelig har de studerendes frafald på første studieår på DTU’s civilbacheloruddannelse og diplomingeniøruddannelse været faldende fra 18,2 pct. (baseline, 2020-tal/årgang 2019) til 12,9 pct. i 2025 (2024-tal/årgang 2023). Igennem kontraktperioden har DTU igangsat en række indsatser og aktiviteter, der skal understøtte og sikre høj faglig kvalitet i uddannelserne og god trivsel. Eksempelvis har DTU løbende evalueret sin
uddannelsesportefølje med inddragelse af internationale ekspertpaneler. Derudover har DTU i 2022 bl.a. udviklet og implementeret et tværgående, obligatoriske innovationskursus på kandidatuddannelsen, som løbende er blevet evalueret og justeret igennem perioden. Endvidere er der siden 2023 arbejdet målrettet med DTU’s nye koncept for studiestarten, hvor fokus er på det nære faglige og sociale miljø på DTU’s campusser. I 2025 har universitetet afsluttet revisionen af diplomingeniøruddannelsen, hvor bl.a. to nye matematiske grundkurser er implementeret. For at øge trivslen har DTU iværksat en række initiativer. DTU Students’ Culture Hub har igennem årene afholdt en række events og aktiviteter med fokus på at skabe et mere inkluderende campusmiljø og bekæmpe ensomhed. Som led heri er der bl.a. etableret en række fællesskaber (Amateur Theatre Community, Community Garden, Table Top role Playing, Fibre Arts, Jugger), der skal bringe studerende sammen. Endeligt har DTU i kontraktperioden gennemført en række tiltag til forbedring af DTU’s campus- og studiemiljø, hvor der bl.a. er etableret en grøn udendørs-studiemiljøzone med nyt vandbassin og arena på Kemitorvet samt moderniseret bygninger og auditorier på DTU’s campusser.
STRATEGISK MÅL 4
DTU skal medvirke til at skabe et mere bæredygtigt samfund og udnytte digitaliseringens muligheder
DTU vil demonstrere universitetets satsning på forskning, der bidrager til en bæredygtig udvikling af samfundet ved at udvikle metode og måldata, der bl.a. inddrager FN-bæredygtighedsmål. Samtidig vil DTU bidrage til at styrke forskningen og udviklingen i systemisk og kvantitativ bæredygtighed, og dermed aktivt bidrage til den grønne omstilling af samfundet. DTU vil udvikle en international hub, der tilbyder rådgivning inden for bæredygtig samfundsomstilling. DTU vil ligeledes fokusere på anvendelsen og udviklingen af nye digitale læringsværktøjer- og metoder, samt styrke og synliggøre digitaliseringen i forskningen og dermed den digitale transformation.
Institutionens vurdering af det strategiske mål
DTU vurderer samlet set, at der er en tilfredsstillende udvikling i målet.
DTU har i kontraktperioden igangsat en række aktiviteter, herunder hjemtaget en række bevillinger fra offentlige og private fonde, der skal understøtte udviklingen af et bæredygtigt samfund. Eksempelvis har Novo Nordisk Fonden bevilget godt en milliard til initiativet ”Novo Nordisk Foundation Biotechnology Research Institute for the Green Transition” (BRIGHT), der skal accelerere udviklingen af biologisk baserede produkter og løsninger. Derudover har DTU bl.a. etableret Center for Absolut Bæredygtighed, oprettet en dekanstilling med ansvar for bæredygtighedsområdet, implementeret bæredygtighed i uddannelserne, herunder udviklet et obligatorisk kursus i kvantitativ bæredygtighed på kandidatuddannelsen, udarbejdet kommunikationsmateriale der beskriver DTU’s seks styrkepositioner på bæredygtighedsområdet samt udviklet et charter for bæredygtighed. Endeligt er der etableret en online-platform ’Advisory Showcase’, der gør det muligt at fremsøge et bredt udsnit af DTU’s rådgivningsrapporter indenfor bl.a. bæredygtig samfundsomstilling. Endvidere har DTU i kontraktperioden
iværksat en række indsatser, der skal understøtte det digitale område. Eksempelvis blev der i 2023 i regi af DTU Skylab etableret et fælles forum for digitale ph.d.er, mens den første digitale hub, ”Digital Discovery of Clean Energy Materials”, blev lanceret. Derudover har universitetet i 2024 oprettet en infohub, der skal understøtte undervisere i brugen af generativ AI i undervisning og til eksamen. Endvidere er der udviklet en digital diplomingeniøruddannelse i Maskinteknik og en digital bacheloruddannelse i Teknologi. Endeligt har DTU i 2025 etableret et Digitaliserings Akademi (DA), der har til opgave at integrere digitalisering og data science i alle DTU’s uddannelser. For at understøtte den digitale campusudvikling har DTU igennem årene bl.a. videreudviklet DTU-appen, og der er udviklet et dashboard, som viser historisk og aktuelt energiforbrug på bygningsniveau (i kWh og CO2-udledning).
For så vidt angår indikatorer på det digitale område ligger gennemsnittet for andelen af digitalisering i DTU’s publikationer på tværs af de 5 kategorier på 6,1 pct. mod en baseline på 4,8 pct. i 2020. DTUstuderendes vurdering af, hvorvidt de finder det nemt at bruge virtuelle værktøjer, ligger i 2025 på 3,98 på en skala fra 1-5, mod 3,6 i 2020 (baseline).
STRATEGISK MÅL 5
DTU skal positionere sig som samfundets førende ekspert på området for teknisk videnskab
DTU vil løbende optimere rådgivnings processen for at sikre, at universitetets rådgivning til stadighed er kendetegnet ved, og giver sikkerhed for, ydelsernes kvalitet, uvildighed og rettidighed. Yderligere ønsker DTU at opdyrke nye forretnings- og rådgivningsområder, der udspringer af myndighedernes øgede behov for digitale løsninger og bæredygtig forandring.
Institutionens vurdering af det strategiske mål
DTU vurderer samlet set, at der er en tilfredsstillende udvikling i målet.
DTU har i kontraktperioden igangsat en række aktiviteter og indsatser med henblik på at positionere universitetet som samfundets førende ekspert på området for teknisk videnskab. DTU har strategiske rammeaftaler med Ministeriet for Fødevarer, Landbrug og Fiskeri, Miljøministeriet, Transportministeriet, Klima-, Energi- og Forsyningsministeriet samt Sundhedsministeriet. I 2022 iværksatte DTU et projekt til optimering af myndighedsbetjeningen via gennemførsel af årlige målinger af myndighedernes hhv. institutternes tilfredshed med rådgivningsprocessen. Uddannelses- og Forskningsstyrelsen foretog i 2024 et eftersyn af den forskningsbaserede myndighedsbetjening. Eftersynsrapporten pegede sammenfattende på, at modellen for den forskningsbaserede myndighedsbetjening fortsat fungerer og leverer kompetent myndighedsbetjening. Derudover har DTU i 2022 og 2023 gennemført sektorudviklingsprojekter om hhv. automatisering inden for Life Sciencesektoren sammen med bl.a. DI Life Science og LIF og energiøer i samarbejde med
Dansk Byggeri og Green Power Denmark. I 2023 indgik DTU en ny rammeaftale med Forsvarets Efterretningstjeneste om forskningsbaseret myndighedsbetjening inden for forsvars- og sikkerhedsområdet, mens der i 2024 blev afsat midler til etablering af et nyt forskningscenter på DTU, der skal medvirke til at forebygge, inddæmme og oprense forurening med PFAS. Ligeledes i 2024 gik DTU og Region Hovedstaden sammen om at etablere et Teknisk Universitetshospital (TUH) med henblik på bl.a. at skabe et fælles forsknings- og innovationsmiljø i den absolutte top. I 2025 er centret Arctic DTU blevet reorganiseret og styrket, så det i højere grad kan navigere i og koordinere DTU’s rolle i det arktiske indenfor universitetets kerneområder. Centret Security DTU har tilsvarende i 2025 spillet en fremtrædende rolle ift. at samle og koordinere universitetets dialog med bl.a. Forsvarsministeriet, Forsvarsministeriets Materiel- og Indkøbsstyrelse, FE, PET, Nationalt Forsvarsteknologisk Center (NFC), m.fl. De eksterne indtægter på rammeaftalerne om forskningsbaseret myndighedsbetjening og den direkte kontraktsum på rammeaftalerne viser et nogenlunde konstant forhold igennem hele kontraktperioden.
STRATEGISK MÅL 6
DTU skal være erhvervslivets foretrukne samarbejdspartner
DTU vil udbygge sit økosystem for innovation og entreprenørskab, og stræbe efter et stadigt tættere samarbejde med omverdenen, herunder forskningstunge virksomheder. DTU vil bl.a. aktivt engagere sig i samarbejder med de danske klyngeorganisationer og GTS’er. Samtidig er det en målsætning at være en mere synlig partner for erhvervslivet, hvilket bl.a. skal forløses gennem en række partnerskabsinitiativer.
Institutionens vurdering af det strategiske mål
DTU vurderer samlet set, at der er en tilfredsstillende udvikling i målet.
DTU har i kontraktperioden iværksat en række aktiviteter og indsatser med henblik på at styrke samarbejdet med erhvervslivet og udbygge sit økosystem for innovation og entreprenørskab. DTU har i perioden 2022-2024 samlet set haft 998 sampublikationer i gennemsnit pr. år med private virksomheder samt myndigheder, hospitaler/SSI og GTS-institutter, hvilket er en stigning på 11,6 pct. i forhold 894 sampublikationer (baseline) i perioden 2018-2020. Endvidere er 88 pct. af de afsluttende diplomingeniørprojekter og 43 pct. af kandidatspecialerne i perioden 2024-25 gennemført i samarbejde med en virksomhed. Derudover deltog DTU i 2025 i 96 innovationsprojekter på tværs af de 14 nationale viden- og erhvervsklynger, hvilket er en stigning på 15,6 pct. i forhold til baseline på 83 projekter 2021, og har dermed øget samarbejdet med erhvervsfremmesystemet. Endeligt har DTU igennem perioden fortsat sit tætte samarbejde med erhvervslivet, og i 2025 havde universitetet 1.463 samarbejder med industrien.
Derudover har DTU igennem sine partnerskabsinitiativer etableret corporate partnerskaber, der er strategiske, samarbejder om forskning, talentudvikling og rekruttering med hhv. Novo Nordisk, Novonesis, Mærsk, IFF, AGC Biologics og
Andel Energi, og samarbejder med en række virksomheder i regi af Talent Partnerprogrammet. Endvidere har DTU igennem et stort antal projekter samarbejdet med de 14 nationale klynger, SMV’er og GTS-systemet. For at understøtte DTU’s innovationsog entreprenørskabsaktiviteter er DTU SkyFactory i 2025 blevet etableret. DTU SkyFactory er en iværksætterhub, der skal hjælpe DTU-start-ups med skaleringspotentiale til at blive vækstvirksomheder, som kan styrke Europas konkurrenceevne. Derudover har DTU under det danske EU-formandskab arrangeret innovationskonferencen ASCEND om styrkelse af EU’s deep tech-innovation. Endvidere har DTU været medstifter af initiativet Rise Europe, der er et netværk af førende opstartsmiljøer fra 14 europæiske lande, som arbejder sammen om at styrke europæiske startups og fremme Europas teknologiske suverænitet. Initiativet Next Generation by DTU Skylab, som universitetet har iværksat, arbejder med, hvordan nye digitale teknologier kan fremme inklusion og bæredygtige løsninger. Endeligt har DTU igennem kontraktperioden styrket samarbejdet med det lokale erhvervsliv og øget sin tilstedeværelse i hele Danmark. Eksempelvis er der udbudt uddannelser i Kalundborg og Hirtshals, etableret Residential Colleges, og der er afholdt en række forskellige studieaktiviteter, herunder 3-ugers kursus, ph.d.-skole, case competition og praktik i Hirtshals, Rødby (Femern), Kalundborg, Skive og på Bornholm.
Forventninger til det kommende år
DTU vil i 2026 fortsætte arbejdet med at udvikle og nyttiggøre natur- og teknisk videnskab til gavn for samfundet. Det sker med afsæt i universitetets nye strategi 2026-2031 "Til gavn for samfundet siden 1829", der ruster DTU til en foranderlig verden og understreger universitetets rolle som et af Europas førende tekniske universiteter. Strategien sætter en klar retning for DTU’s bidrag til Europas teknologiske fremtid, bæredygtighed og innovation samt for styrkelsen af videnskab som fundament for demokrati. Strategien viderefører det arbejde, DTU allerede gør rigtig godt – og skal stræbe efter at gøre endnu bedre de kommende år.
Strategien sætter en tydelig retning for universitetets arbejde med bæredygtig teknologisk omstilling og et europæisk førerskab i kritiske teknologier. Dette afspejles i Uddannelsesog Forskningsministeriets roadmap for nye forskningsinfrastrukturer i perioden 2025-2028, hvor DTU er hovedansøger på fire store infrastrukturprojekter. De fire DTU-ledede projekter omfatter avancerede faciliteter til realtidssimulering af energisystemer, nyt laboratorie på Risø Campus til forskning i moderne atomkraft, et unikt testanlæg til fusionsforskning, samt design og produktion af avancerede mikrochips. At disse projekter er optaget i roadmappet, viser hvordan DTU’s strategiske prioriteringer omsættes til konkrete investeringer i forskningsinfrastruktur, der både styrker den grønne omstilling og sikrer europæisk førerskab inden for kritiske teknologier i de kommende årtier.
I 2026 etablerer DTU den første af flere nye uddannelser på DTU Risø Campus med forventet studiestart i september. Diplomingeniøruddannelsen i Industriel Teknologi bliver en central del af den strategiske udvikling af DTU Risø Campus. Visionen er at skabe et internationalt hotspot inden for energi- og bioteknologi med fokus på innovation, hvor forskning, uddannelse og virksomheder mødes om at udvikle, teste og markedsprøve fremtidens grønne løsninger.
DTU styrker også sit fokus på Arktis inden for forskning, uddannelse, innovation og forskningsbaseret rådgivning. Arbejdet omfatter både udviklingen af Campus Sisimiut og universitetets strategiske rolle i regionen, og understøtter DTU’s ambitioner om videnskabeligt lederskab, ansvarlig teknologiudvikling og bidrag til Europas sikkerhed og styrkepositioner i Arktis.
Sideløbende træder byggeriet af Danmarks kommende forskningsskib Dana V ind i en ny fase. Efter køllægningen i efteråret, er næste vigtige milepæl i byggefasen søsætningen af skroget. Skibet, der erstatter Dana IV, bliver en højteknologisk, næsten støjfri platform til avanceret hav- og arktisforskning og styrker både Danmarks og Europas forskningskapacitet inden for klima, havmiljø og sikkerhed. Studerende får mulighed for at følge dele af konstruktionen som led i DTU’s mål om at uddanne Europas mest kompetente ingeniører. Dana V forventes afleveret i 2027.
Samlet set går DTU ind i 2026 med en tydelig strategisk retning og en stærk teknologisk position. Med markante investeringer i forskning, nye uddannelser, et styrket aftryk i Arktis og et nyt forskningsskib på vej, er fundamentet lagt for, at DTU kan løfte sit ansvar som et af Europas førende tekniske universiteter.
Forventet økonomisk udvikling
DTU´s budget for 2026 har samlede indtægter på 7.110 mio. kr. og udviser et positivt resultat på 6 mio. kr. Der forventes finanslovsindtægter i henhold til Finanslov 2026 på 3.293 mio. kr., hvilket er en stigning på 144 mio. kr. i forhold til 2025.
Desuden forventes der indtægter fra eksterne midler til forskning inklusive anlægsdonationer på 2.963 mio. kr., hvilket er en stigning på 136 mio. kr.
På diplomingeniørretningen
Arktisk Byggeri og Infrastruktur på DTU Campus Sisimiut arbejder de studerende med at udvikle bæredygtige bygge- og infrastrukturløsninger til de krævende arktiske forhold. De lærer at designe huse, veje og anlæg, som f.eks. kan modstå frost og kraftig vind. Uddannelsen gør de studerende klar til at forme et Arktis i forandring og skabe sammenhæng i Grønland og andre arktiske områder.


03 Regnskab
· Anvendt regnskabspraksis
· Resultatopgørelse
· Balance
· Egenkapital
· Pengestrømsopgørelse
· Noter
· Særlige specifikationer

Hos DTU Nanolab bygges en kvantechip med det formål at forbedre kvantekommunikation og derved mindske informationstab når signaler sendes gennem fiberkabler.
Anvendt regnskabspraksis
Regnskabsgrundlag
DTU’s årsrapport udarbejdes efter lov om statens regnskabsvæsen mv., bekendtgørelse om statens regnskabsvæsen (BEK nr. 116 af 19. februar 2018), retningslinjerne i Finansministeriets Økonomisk Administrative Vejledning, bekendtgørelse af lov om universiteter (universitetsloven) LBK nr. 391 af 10. april 2024, bekendtgørelse om tilskud, regnskab og revision m.v. ved universiteterne (BEK nr. 912 af 25. juni 2025) samt Uddannelsesog Forskningsstyrelsens (UFS) retningslinjer for udarbejdelse af årsrapport.
Der er i overensstemmelse med statens regnskabsregler herom ikke udarbejdet koncernregnskab.
Årsrapporten er aflagt i DKK 1.000.
Fælles kontoplan og formålsfordeling
DTU har implementeret den fælles kontoplan for uddannelsesinstitutioner under Uddannelses- og Forskningsministeriet (UFM) i henhold til UFS’s konterings- og fordelingsvejledning med virkning fra 2021.
DTU har til initial kontering af omkostninger, der ikke entydigt vedrører ét hovedformål, primært anvendt metode 3 suppleret med metode 2, jf. konterings- og fordelingsvejledningens afsnit 1.5.1.
DTU har til fordeling af omkostninger til hovedformål benyttet følgende overordnede principper for afgrænsning af omkostningspuljer og valg af fordelingsmetoder, jf. konterings- og fordelingsvejledningens afsnit 1.5.2 (for poster, der ikke entydigt vedrører ét hovedformål):
Omkostningerne opdeles i puljerne 1) Timeallokeret løn til videnskabeligt personale, undervisere mv., 2) Timeallokeret Ph.d.-løn, 3) Timeallokeret løn til administrativt personale, 4) Ikke-allokeret løn og 5) Driftsomkostninger. Ved puljerne 1) Timeallokeret løn til videnskabeligt personale, undervisere mv. og
2) Timeallokeret Ph.d.-løn anvendes en kombination af forbrugsopgørelse (fx kursusenheder for formål
1, uddannelse) og normtid som fordelingsmetode. Ved de øvrige puljer anvendes primært årsværk (efter de to første puljer er fordelt) eller konkrete forbrugsopgørelser som fordelingsmetode.
Årsrapportskabelon
Årsrapporten er aflagt i henhold til den fælles årsrapportskabelon for uddannelsesinstitutioner under UFM.
Dispensationer
Artsopdelt opstilling af resultatopgørelsens omkostningsside:
UFM har i juni 2021 givet universiteterne dispensation fra den fælles årsrapportskabelon for så vidt angår opstillingen af resultatopgørelsens omkostningsside med henblik på, at universiteterne i årsrapporten kan afrapportere omkostningerne i resultatopgørelsen artsopdelt.
Donationer:
UFM har givet dispensation til, at DTU i årsrapporten for 2021 og i fremtidige årsrapporter, kan videreføre den hidtidige regnskabspraksis for donationer, hvor der som modpost til de under anlægsaktiver indregnede værdier, indregnes en periodeafgrænsningspost, der benævnes Periodiserede donationer. Denne post opløses og indregnes i resultatopgørelsen som indtægt i samme takt som afskrivningen af de anlægsaktiver, den vedrører.
Internt statsligt køb og salg:
Selvejesektoren skal ikke bruge de særlige statslige arter til samhandel med stat, kommune og andre selvejere. I stedet anvendes de relevante artskonti. Data vedrørende samhandlen opgøres i stedet en gang årligt og leveres til styrelsen, som samlet leverer disse data til Danmarks Statistik, der skal bruge dem i forbindelse med udarbejdelsen af nationalregnskabet.
Indregning og måling
Regnskabet er udarbejdet med udgangspunkt i kostprisprincippet. Indtægter indregnes i resultatopgørelsen i takt med, at de optjenes.
I resultatopgørelsen indregnes alle omkostninger, der er afholdt for at opnå årets indtægter, herunder afskrivninger, nedskrivninger og hensatte forpligtelser samt tilbageførsler som følge af ændrede regnskabsmæssige skøn.
Aktiver indregnes i balancen, når det er sandsynligt, at fremtidige økonomiske fordele vil tilflyde institutionen, og aktivets værdi kan måles pålideligt. Forpligtelser indregnes i balancen, når det er sandsynligt, at fremtidige økonomiske fordele vil fragå institutionen, og forpligtelsens værdi kan måles pålideligt.
Ved indregning og måling er der taget hensyn til forudsigelige tab og risici, der er fremkommet, inden årsrapporten er aflagt, og som be- eller afkræfter forhold, der eksisterede på balancedagen.
Særlige områder
Omregning af fremmed valuta:
Transaktioner i fremmed valuta er i årets løb omregnet til transaktionsdagens kurs.
Gevinster og tab, der opstår på grund af forskelle mellem transaktionsdagens kurs og kursen på betalingsdagen, indregnes løbende i resultatopgørelsen under Øvrige driftsomkostninger.
Resultatopgørelsen
Statstilskud:
Driftstilskud fra staten indregnes som indtægt i det år, som de er ydet for. Driftstilskud fra staten består af en række forskellige tilskud, bl.a. faste uddannelsestilskud, tilskud til forskning og udvikling samt aktivitetsbestemte tilskud (taxametertilskud).
Øvrige tilskud:
Indtægter fra eksterne tilskudsgivere, herunder til forskningsprojekter, indregnes i takt med, at omkostningerne afholdes. Ikke anvendte midler indregnes under passiverne som en kortfristet gældsforpligtelse under kategorien ”forudbetalte bundne tilskud”.
Salg af varer og tjenesteydelser samt andre indtægter: Salg af varer og tjenesteydelser inkluderer bl.a. indtægter fra indtægtsdækket virksomhed, herunder fra kursusvirksomhed. Andre indtægter inkluderer bl.a. deltagerbetaling vedr. studieture og feltarbejde, udlejning af lokaler samt gevinst ved salg af bygninger. Salg af varer og tjenesteydelser samt andre indtægter indregnes i resultatopgørelsen i takt med, at de indtjenes.
Omkostninger:
Omkostninger omfatter de omkostninger, der er afholdt for at opnå årets indtægter. Omkostninger dækker over personaleomkostninger, husleje, af- og nedskrivninger og øvrige driftsomkostninger, samt tab ved salg af anlægsaktiver.
Omkostningerne er opgjort på formålene:
• Uddannelse
• Forskning og udvikling
• Formidling og vidensudveksling
• Myndighedsbetjening, rådgivning og øvrige ydelser
• Boligformål
• Generelle fællesomkostninger
• Bygninger og bygningsdrift.
Finansielle poster:
Finansielle poster omfatter finansielle indtægter og omkostninger. Finansielle poster omfatter renter samt realiserede og ikke-realiserede kursreguleringer på værdipapirer.
Balancen
Aktiver
Aktiveringsgrænse:
Anlægsaktiver, hvor den historiske kostpris overstiger grænsen på 100 t. kr. afskrives efter den lineære metode.
Levetider:
Afskrivningsgrundlaget for immaterielle anlægsaktiver fordeles lineært over aktivernes forventede brugsret, der udgør:
Immaterielle anlægsaktiver
Erhvervede koncessioner, patenter, licenser, software m.v.:
- Licenser m.v.
Levetid
3-5 år
- Andre erhvervede rettigheder, hvor levetiden er kontraktlig fastsat Rettighedens levetid
Færdiggjorte udviklingsprojekter:
- Specialudvikling af et forretningskritisk system
8 år
- Tilpasning eller nyudvikling af applikationer til et i forvejen eksisterende standardsystem 5 år
Internt oparbejdede aktiver med rettigheder som følge af et udviklingsprojekt Rettighedens levetid
Immaterielle udviklingsprojekter under opførelse Afskrives ikke, men overgår til færdige udviklings projekter ved ibrugtagning
Afskrivningsgrundlaget for materielle anlægsaktiver fordeles lineært over aktivernes forventede brugsret, der udgør:
Materielle anlægsaktiver
Grunde og arealer
Bygninger
Igangværende arbejder for egen regning
Installationer:
- Almindelige installationer
Levetid
Afskrives ikke
50 år
Afskrives ikke
20 år
- Særlige installationer 10-20 år
Indretning af lejede lokaler
Transportmateriel, inkl. skibe
- Biler m.v.
10 år eller lejemålets levetid
5-8 år
- Skibe 30-40 år
Produktionsanlæg, maskiner og udstyr:
- Laboratorie- og produktionsteknisk inventar og udstyr
- Skovnings-, entreprenør-, feje- og gravemaskiner
IT-udstyr
3–15 år
3–15 år
3–5 år
Inventar 3–5 år
Immaterielle anlægsaktiver:
En integreret del af DTU’s virksomhed er omfattende forskningsaktiviteter. Som altovervejende hovedregel er forskningen ikke kommerciel, og den omkostningsføres derfor løbende i takt med afholdelsen. Opfindelser, der er klart definerede og identificerbare, hvor den tekniske udnyttelse og et potentielt marked er påvist, og der forventes at kunne indgås en aftale med en ekstern samarbejdspartner, indregnes som immaterielle anlægsaktiver. Udgifter til patenter registreres som igangværende arbejde, indtil kostprisen overstiger 50 t. kr. Herefter påbegyndes afskrivninger, som foretages over 5 år. Når kostprisen overstiger 100 t. kr. forlænges levetiden med 5 år. Patenter under 50 t. kr. omkostningsføres i resultatopgørelsen. Der finder løbende en vurdering sted af udnyttelsesmulighederne, som danner grundlag for fastsættelsen af værdien af rettighederne og den økonomiske levetid.
Kunstværker og samlinger
Kunstværker og –samlinger indregnes uden værdi.
Finansielle anlægsaktiver
Kapitalandele, inklusive andelsbeviser: Virksomheder, i hvilke DTU besidder flertallet af stemmerettighederne eller på anden måde øver bestemmende indflydelse, betragtes som dattervirksomheder. Kapitalandele i dattervirksomheder indregnes og måles til kostpris eller lavere baseret på dattervirksomhedernes egenkapital. Andre værdipapirer og kapitalandele omfatter aktier eller anparter, som universitetet har modtaget som betaling for udnyttelse eller overdragelse af intellektuelle rettigheder (patenter og patentansøgninger). Aktierne og anparterne kan værdiansættes til skønnet markedsværdi. Hvis en skønnet markedsværdi ikke kan opgøres pålideligt, kan aktierne og anparterne værdiansættes til indre værdi eller ultimativt til kostpris. Med henblik på kommercialisering af opfindelser, som er skabt af forskere ansat på universitetet, etableres aftaler med eksterne partnere ved oprettelse af nye selskaber. Dette sker blandt andet ved, at universitetet indskyder rettigheder (licensaftaler eller patenter og patentansøgninger) til opfindelser i selskaberne mod som vederlag at modtage aktier eller anparter. Universitetet kan også indgå licensaftaler, der indeholder optioner på senere overdragelse af rettigheder. De modtagne optioner kan give rettighed eller pligt til på et senere tidspunkt at tegne aktier eller anparter i selskaberne til en
forud fastsat kurs, hvis betaling for aktier eller anparter ikke sker som kontanthandel. Såfremt optioner skønnes at få en kommerciel værdi, oplyses rettighederne som eventualaktiver.
Afledte finansielle instrumenter: Afledte finansielle instrumenter, der er klassificeret som og opfylder betingelserne for sikring af fremtidige transaktioner, indregnes første gang i balancen til kostpris og måles efterfølgende til dagsværdi på balancedagen, hvor ændringer til dagsværdi indregnes direkte på egenkapitalen.
Ved negativ dagsværdi af finansielle instrumenter indregnes under langfristede eller kortfristede gældsforpligtelser. Ved positiv dagsværdi af finansielle instrumenter indregnes under finansielle anlægsaktiver eller omsætningsaktiver.
Omsætningsaktiver Omsætningsaktiver omfatter aktiver med en brugstid på under ét år modsat anlægsaktiver, der har en brugstid på over ét år. Omsætningsaktiverne omfatter varebeholdninger, tilgodehavender, værdipapirer og likvide beholdninger.
Tilgodehavender fra salg af varer og ydelser: Tilgodehavender fra salg af varer og tjenesteydelser værdiansættes i balancen til pålydende værdi med fradrag af nedskrivning til imødegåelse af tab. Nedskrivninger til imødegåelse af tab indregnes i resultatopgørelsen.
Tilgodehavender fra igangværende tilskudsaktivitet: I det omfang DTU afholder omkostninger til aktiviteter, som er tilskudsdækket i henhold til aftaler med eksterne tilskudsgivere, men hvor tilskuddene endnu ikke er indbetalt, indregnes de tilskud, som institutionen har erhvervet ret til, som tilgodehavender fra igangværende tilskudsaktiviteter.
Andre tilgodehavender: For ikke-fakturerede ydelser vedrørende administrative fællesskaber i universitetsregi registreres partnernes omkostninger på en udlægskonto i overensstemmelse med UFS’s konterings- og fordelingsvejledning.
Værdipapirer:
Værdipapirer indregnes, når de anskaffes. Værdipapirer, som indgår i likviditetsberedskabet, indregnes i balancen som et omsætningsaktiv.
Likvide beholdninger:
Likvider værdiansættes til pålydende værdi. Likvide beholdninger består af indestående på bankkonti og kassebeholdning.
Passiver
Hensatte forpligtelser:
Hensatte forpligtelser indregnes, når institutionen som følge af en tidligere begivenhed indtruffet før eller på balancedagen, har en retlig eller faktisk forpligtelse, som er sandsynlig, men uvis med hensyn til præcis størrelse eller afviklingstidspunkt.
Forudbetalte bundne tilskud:
Modtagne tilskud vedrørende tilskudsaktiviteter, der dækker omkostninger, som endnu ikke er afholdt, indregnes som forudbetalte bundne tilskud. De modtagne tilskud reduceres løbende ved indtægtsføring svarende til de afholdte omkostninger til tilskudsaktiviteterne.
Feriepengeforpligtelsen:
Til opgørelse af feriepengeforpligtelsen anvendes den gennemsnitlige metode, hvor opgørelsen tager udgangspunkt i et gennemsnitligt ferietilgodehavende for den samlede medarbejdergruppe.
Eventualaktiver og -forpligtelser
Eventualaktiver og -forpligtelser omfatter fremtidige økonomiske fordele henholdsvis forpligtelser, som først kan bekræftes efter en eller flere usikre fremtidige begivenheder, og som ikke allerede er indregnet i regnskabet. Eventualaktiver og -forpligter indregnes ikke i balancen, men oplyses i en note.
Pengestrømsopgørelsen
Pengestrømsopgørelsen viser pengestrømme for året fordelt på drifts-, investerings- og finansieringsaktivitet, samt hvorledes disse pengestrømme har påvirket årets likvide midler. Pengestrømsopgørelsen udarbejdes efter den indirekte metode og tager udgangspunkt i årets resultat.

RESULTATOPGØRELSE
1. JANUAR – 31. DECEMBER

t. kr.
Mellemregning med Uddannelses- og Forskningsministeriet
pr. 1. januar 2002
resultat
egenkapital
i alt
finansielle instrumenter
gældsforpligtelser i alt
Kortfristet del af langfristet gæld til stat, kommuner, banker og realkreditinstitutter
bundne tilskud
Børne- og Undervisningsministeriet
Kortfristede
I tilknytning til balancen oplyses desuden følgende:
EGENKAPITAL
pr. 1. januar 2002
Overført resultat
Saldo primo
Årets bevægelser
Saldo ultimo
Øvrig egenkapital
Saldo
Heraf udgør værdiregulering af ikke-konverterbare finansielle instrumenter
Saldo primo
Årets
Saldo ultimo
Heraf udgør fusionskorrektioner
Saldo
Årets bevægelser
Øvrige egenkapitalkorrektioner
Saldo primo -4.224 -4.224
Årets bevægelser
Saldo ultimo -4.224 -4.224
PENGESTRØMSOPGØRELSE
Af- og nedskrivninger på anlægsaktiver
Avance/tab ved afhændelse af anlægsaktiver
Periodiserede anlægsdonationer
Avance/tab ved afhændelse af anlægsdonationer
Øvrige ikke-kontante driftsposter
Tilbageførsel af poster uden likviditetseffekt
Ændring i tilgodehavender ekskl. igangværende tilskudsaktivitet
Ændring i igangværende tilskudsaktivitet
Ændring i hensatte forpligtelser
Ændring i kortfristede gældsforpligtelser ekskl. forudbetalte bundne tilskud
Ændring i forudbetalte bundne tilskud
Ændringer i driftskapital
Pengestrømme
driftsaktivitet i alt
Køb af immaterielle anlægsaktiver
Salg af immaterielle anlægsaktiver
Køb af materielle anlægsaktiver
Pengestrømme fra investeringsaktivitet i alt
Optagelse af bank- og realkreditgæld 0 0
Afdrag på bank- og realkreditgæld
Modtagne anlægsdonationer
Pengestrømme
Likvide beholdninger inkl. værdipapirer i alt, primo
Likvide beholdninger inkl. værdipapirer i alt, ultimo
Note 1 Statstilskud (t. kr.)
Uddannelsestilskud, heltidsuddannelse
Uddannelsestilskud, deltidsuddannelse/åben uddannelse 3.152
Uddannelsestilskud fra BUVM
Tilskud til øvrige formål
Tilskud til forskning og udvikling
Tilskud til forskningsbaseret myndighedsbetjening
I alt
Note 2 Øvrige tilskud (t. kr.)
Tilskud til forskning fra offentlige danske kilder mv.
Tilskud til forskning fra private danske kilder mv.
Tilskud til forskning fra EU
Tilskud til forskning fra udenlandske kilder mv.
Andre tilskudsfinansierede aktiviteter
Periodiserede anlægsdonationer
Ekstern rekvirentbetaling
Note 3 Salg af varer og tjenesteydelser (t. kr.)
Kursusvirksomhed (indtægtsdækket virksomhed)
Øvrigt salg af varer og tjenesteydelser:
Heraf kommercielt salg af varer og tjenester
Heraf øvrigt salg af varer og tjenesteydelser under ordinær drift
De regnskabsmæssige indtægter og omkostninger vedrørende administrative fællesskaber i universitetsregi, i alt 237 mio. kr., er udeholdt i 2025, i henhold til Uddannelses- og Forskningsministeriets konteringsvejledning.
Note 4 Andre indtægter (t. kr.)
Deltagerbetaling, heltidsuddannelse
Deltagerbetaling, deltidsuddannelse / åben uddannelse
Udlejning af lokaler og udstyr
Salg af bygninger, grunde, immaterielle og materielle anlæg
Øvrige indtægter
Note 5 Driftsomkostninger (t. kr.)
Uddannelse
Forskning og udvikling
Formidling og vidensudvikling
Myndighedsbetjening, rådgivning og øvrige ydelser
Kostafdeling og kollegier
Generelle fællesomkostninger
Bygninger og bygningsdrift
Efter dialog med UFS flyttes en post på 12 mio. kr. tilbage til Boligformål fra formål Bygninger og bygningsdrift. I årsrapport 2024 indgik posten på 12 mio. kr. i formål Bygninger og bygningsdrift. I 2025 indgår posten i Boligformål.
Heraf enheder, hvor DTU er værtsuniversitet (UNIIT inkl. Nyt SIS, DeiC og forskningsnettet) (t. kr.)
Formidling og vidensudvikling
Myndighedsbetjening, rådgivning og øvrige ydelser
Generelle fællesomkostninger
Bygninger og bygningsdrift
For 2025 er regnskabspraksis ændret, så administrative fællesskaber i tilknytning til ovenstående enheder håndteres som udlæg. I 2024 tallene indgik administrative fællesskaber i ovenstående indlejrede enheder.
Note 6 Finansielle poster (t. kr.)
Renteomkostninger og andre finansielle omkostninger
Kurstab på værdipapirer 2.099 44 Finansielle omkostninger i alt
Resultat af finansielle
Note 7 Immaterielle anlægsaktiver (t. kr.)
Erhvervede koncessioner, patenter, licenser, software, færdiggjorte udviklingsprojekter
Overført til/fra igangværende arbejder for egen regning
Afgang i årets løb
Overført til/fra andre poster
Anskaffelsessum
Tilbageførte af- og nedskrivninger
Akkumulerede af- og nedskrivninger ultimo
Bogført værdi 31. december 2025
Note 8 Materielle anlægsaktiver (t. kr.)
Bogført værdi 31. december 2025
Note 9 Kapitalandele i dattervirksomheder (t. kr.)
Navn på selskab Hjemmelsgrundlag for erhvervelse af kapitalandele
A/S Aktstykke af 17. december 2003
Ventures A/S
281 af 16. august 2001
Dansk Fundamental Metrologi A/S Aktstykke 14 af 24. oktober
Navn på selskab
Indtægter i regnskabsåret
Omkostninger i regnskabsåret DTU Science
Note 10 Øvrige kapitalandele (t. kr.)
Navn på selskab Hjemmelsgrundlag for erhvervelse af kapitalandele Indskud i året
Blade Test Centre A/S Aktstykke 110 af 2005 0
Øvrige kapitalandele
ejerandel < 20% Forskerpatentloven 0
Note 11 Deposita (t. kr.)
Deposita vedrørende lejemål
Heraf opført som finansiel anlægsaktiv
indskud
Heraf opført som omsætningsaktiv -Øvrige deposita
Heraf opført som finansiel anlægsaktiv -
Heraf opført som omsætningsaktiv
Note 12 Tilgodehavender fra salg af varer og ydelser (t. kr.)
Tilgodehavender fra salg af varer og ydelser m.v.
Tilgodehavender hos dattervirksomheder 84 150
Reserveret til tab på tilgodehavender fra salg af varer og ydelser m.v.
Note 13 Tilgodehavender fra igangværende tilskudsaktivitet (t. kr.)
Tilgodehavender fra igangværende tilskudsaktivitet
Note 14 Andre tilgodehavender (t. kr.)
Refusionsberettiget købsmoms og elafgift
Ikke-fakturerede ydelser Administrative fællesskaber
Andre tilgodehavender
I alt
Note 15 Øvrige periodeafgrænsningsposter (t. kr.)
Periodeafgrænsningsposter, aktiver Forudbetalte licenser m.v.
Andet
Note 16 Værdipapirer (t. kr.)
Note 17 Hensatte forpligtelser (t. kr.)
Løn - åremål
Fratrædelser/fritstillinger
Øvrige lønrelaterede hensættelser
Retablering Høvsøre og ØsterIld
Hensættelse til tab på igangværende tilskudsaktivitet
Andre hensatte forpligtelser
Note 18 Periodiserede donationer (t. kr.)
Kostpris primo
Tilgang i årets løb
Afgang i årets løb -
Kostpris ultimo
Af- og nedskrivninger primo
Årets af- og nedskrivninger
Afgang i årets løb
Akkumulerede af- og nedskrivninger ultimo
Regnskabsmæssig værdi per 31. december 2025
Heraf:
Note 19a Gæld til realkreditinstitutter
Lån nr. Ejendom
1 Anker Engelunds vej 101A, 2800 Kgs. Lyngby
Lautrupvang 15, 2750 Ballerup
2 Anker Engelunds vej 101A, 2800 Kgs. Lyngby
Lautrupvang 15, 2750 Ballerup
3 Anker Engelunds vej 101A, 2800 Kgs. Lyngby
Lautrupvang 15, 2750 Ballerup
4 Anker Engelunds vej 101A, 2800 Kgs. Lyngby
Lautrupvang 15, 2750 Ballerup
5 Anker Engelunds vej 101A, 2800 Kgs. Lyngby
Lautrupvang 15, 2750 Ballerup
6 Anker Engelunds vej 101A, 2800 Kgs. Lyngby
Lautrupvang 15, 2750 Ballerup
7 Lautrupvang 15, 2750 Ballerup
8 Anker Engelunds vej 101A, 2800 Kgs. Lyngby
Lautrupvang 15, 2750 Ballerup
9 Anker Engelunds vej 101A, 2800 Kgs. Lyngby
Lautrupvang 15, 2750 Ballerup
10 Anker Engelunds vej 101A, 2800 Kgs. Lyngby
Lautrupvang 15, 2750 Ballerup
11 Anker Engelunds vej 101A, 2800 Kgs. Lyngby
Lautrupvang 15, 2750 Ballerup
12 Anker Engelunds vej 101A, 2800 Kgs. Lyngby
Lautrupvang 15, 2750 Ballerup
13 Anker Engelunds vej 101A, 2800 Kgs. Lyngby
Lautrupvang 15, 2750 Ballerup
Note 19b Afledte finansielle instrumenter Lån nr.
1
2
6
9 Renteswap
Positive markedsværdier er opført under aktivposten ”Afledte finansielle poster” med 386,2 mio. kr. Negative markedsværdier er opført under langfristede gældsforpligtelser med 49 mio. kr.
Note 20 Kortfristet del af langfristet gæld til stat, kommuner, regioner, banker og realkreditinstitutter (t. kr.)
Kortfristet del af gæld til realkreditinstitutter
Note 21 Bankgæld (t. kr.)
Korte driftskreditter
Note 22 Øvrige periodeafgrænsningsposter (t. kr.)
Periodisering af basistilskudsbevilling
Periodisering af øvrige finanslovsindtægter
Periodisering af betalingsuddannelser
Øvrige indtægtsperiodiseringer
Periodisering af indtægter vedrørende vindmølleaktiviteter
Note 23 Anden kortfristet gæld (t. kr.)
personskatter m.v.
DeiC egenkapital (administrativt fællesskab)
Uni-IT, egenkapital (administrativt fællesskab)
Legater
Periodisering af refunderede ejendomsskatter
Øvrige forpligtelser
Der er modtaget 149 mio. kr. fra Lyngby-Taarbæk Kommune og SKAT relateret til igangværende tvist om betaling af dækningsafgift for perioden 2018-2025. Sagen afventer afklaring i retsinstans før pengene indtægtsføres eller tilbagebetales.
Note 24 Andre forpligtelser (t. kr.)
Kontraktlige forpligtelser: Boligfonden DTU, vedligeholdelsesforpligtelser lejemål
DTU har i 2013 modtaget 16,4 mio. kr. til samlokalisering fra Bygningsstyrelsen af aktiviteter på Lyngby Campus. Desuden har DTU i 2018 modtaget tilskud på 263 mio. kr. fra Bygningsstyrelsen til samlokalisering af aktiviteter på Lyngby Campus. I tilfælde af salg eller nedrivning af de pågældende bygninger er universitetet kontraktligt forpligtet til at tilbagebetale det fulde tilskud.
Lejeforpligtelser i 2024 er opgjort som det kommende års husleje. Lejeforpligtelser i 2025 er opgjort på baggrund af opsigelsesperioden.
Note 25 Eventualaktiver og -forpligtelser (t. kr.)
Tjenestemænd, rådighedsløn
For ph.d.-studerende indestår universitetet for betaling af de studerendes løn i den treårige periode, hvor deres ansættelsesaftaler er uopsigelige fra universitetets side. Forpligtelsen kan blive aktuel, hvis lønomkostningerne ikke dækkes af virksomheder eller institutioner, der er indgået uddannelsesaftaler med.
Området, hvor universitetet er placeret, var tidligere udlagt som Lundtofte Flyveplads (den nordlige del) og gartneri (sydlige del). I den sydvestlige ende af arealet har der tidligere været en losseplads. Området var oprindeligt en svagt, mod nord skrånende slette, der blev terrasseret i forbindelse med opførelsen af universitetet, hvorfor en meget stor del af bygningerne og terræninstallationerne er opført på/etableret i opfyld. Ved enkelte lejligheder er der konstateret behersket olie- og/eller tungmetalforurening i jorden; det nærmere omfang er ukendt.
Indtægter og omkostninger på virksomhedstyper (t. kr.)
Tilskudsfinansieret forskningsvirksomhed
Andre tilskudsfinansierede aktiviteter
Indtægtsdækket virksomhed (IDV)
Akkumuleret
Lederløn (t. kr.)
Bestyrelse
Legater (t. kr.)
Opgørelse pr. 31. december for fonde og foreninger
Studenterpolitiske aktiviteter (t. kr.)
Studenterpolitiske aktiviteter
I alt
Indskudte midler i fonde, hvis hovedformål er at etablere universitetsnære boliger (t. kr.)
Friplads- og stipendiemidler for universiteterne (t. kr.)
Forbrug (studieåret 1.9.2024-31.8.2025) Takstgruppe
Antal indskrevne studerende på hele eller delvise fripladser Antal modtagere af stipendier Forbrug af fripladser (t. kr.) Forbrug af stipendier (t. kr.) Takst 3
Regnskab (kr.)
Regnskabsår
Overført fra Uddannelses og Forskningsstyrelsen
Overført overskud vedrørende udenlandske betalingsstuderende
Heraf akkumuleret resultat vedrørende udenlandske betalingsstuderende
Afgivne tilsagn til fri-pladser og stipendier til allerede indskrevne studerende i efterfølgende regnskabsår
Det akkumulerede resultat for 2025 er nedskrevet med 5 mio. kr. som følge af opgørelsesfejl af udbetalte stipendier i perioden 2010 til 2024.
Personaleårsværk
Antal årsværk inkl. ansatte på sociale vilkår
Andel årsværk i procent ansat på sociale vilkår

04 Bilag
· Grønt regnskab
· Personale og arbejdsmiljø
· Bestyrelsens og direktionens bestyrelsesposter i selskaber, fonde m.v.

DTU Hirtshals Campus ligger midt i et af Danmarks vigtigste centre for fiskeri og akvakultur og spiller en central rolle i udviklingen af fremtidens bæredygtige fødevareløsninger. Her får studerende og forskere adgang til moderne laboratorier, forsøgsfaciliteter og tæt samarbejde med erhvervet.
Klima- og miljøpåvirkning fra universitetsdriften
1.1 Indkøb
DTU har samlet delpolitikken for bæredygtige indkøb med den overordnede indkøbspolitik og dermed skabt et tydeligt grundlag for den fremadrettede indsats, hvor samarbejde med Statens og Kommuners Indkøbscentral samt Partnerskab for Offentlige Grønne Indkøb understøtter arbejdet med mere bæredygtige indkøb.
EKSEMPLER PÅ TILTAG
Tiltag Udgangspunkt Målsætning 2025 Status 2025 INDKØB
1.1.1 Koncernindkøb har igangsat et projekt, der sikrer kategorisering af alle indkøb, som skal understøtte og højne kvaliteten af data i DTU’s klima- og miljøregnskab – jf. GHG-protokollen.
1.1.2 Yderligere implementering, uddannelse og forankring af Opslagsværket for Grønne Indkøb.
1.1.3 Delpolitikken for bæredygtighed i indkøb sammenskrives med DTU’s indkøbspolitik.
Manglende og usikker kategorisering af indkøb.
At sætte konkrete mål for klimareduktion på indkøbskategorier ved hjælp af korrekt varekategorisering.
Primo 2026 kan vi påbegynde at sætte mål for klimareduktion for indkøbskategorier.
Der forventes fuld implementering og dermed i drift ultimo 2026.
Bæredygtighed i indkøb er i dag en delpolitik til indkøbspolitikken.
85 pct. af alle projektindkøb og rammeaftaler over 100.000 kr. skal efterleve DTU’s indkøbsproces for bæredygtige indkøb.
Ved at integrere bæredygtighed i indkøbspolitikken er der skabt en ramme for, at DTU kan reducere sit miljøaftryk.
I maj 2025 er der i 86 pct. af de indgåede rammeaftaler og projektindkøb taget højde for krav om bæredygtighed.
Delpolitikken for bæredygtige indkøb og DTU’s Indkøbspolitik er sammenskrevet til en ny Indkøbspolitik. Offentliggjort på Inside december 2025.
1.2 Genbrug
Genbrug er blevet en væsentlig del af DTU’s arbejde for ansvarligt ressourceforbrug, hvor digital understøttelse gør det muligt at arbejde med genbrug af både inventar og IT- udstyr på tværs af campusserne.
EKSEMPLER PÅ TILTAG

Tiltag Udgangspunkt Målsætning 2025 Status 2025
GENBRUG
1.2.1 Digital understøttelse af genbrugsindsatsen, der letter arbejdsgangene og forbedrer data og dokumentation.
Derudover fokus på optimering og planlægning af lager for genbrugt inventar.
1.2.2 For at mindske klimabelastningen har DTU lanceret projektet RecycleIT, hvor brugt IT-udstyr bliver solgt videre til certificerede samarbejdspartnere.
DTU har udviklet en praksis for genbrug af inventar.
Erfaringerne gør, at DTU er klar til et øget fokus på systematik og principielle beslutninger, der skal effektivisere indsatsen for genbrug på DTU.
Der manglede en fast procedure for afskaffelse af IT-udstyr på en måde, som kunne reducere klimaaftrykket.
Der er udviklet et digitalt bestillersystem til genbrug, og implementering er igangsat.
DTU Serviceportal er bygget til bestillinger og forespørgsler og er klar til drift. Fuld udrulning forventes i Q1 2026.
En øget bevidsthed om at indsamle større mængder brugt IT-udstyr på et tidligere stadie, mens værdien er højere.
RecycleIT er en integreret del af driften i AIT’s IT Support, og processen for internt genbrug og afsendelse af udstyr til ekstern genbrug er fuldt implementeret.
1.3 Affald og genanvendelse
DTU har arbejdet med affaldssortering, behandling og dokumentation. Krav i udbud og fokus på datakvalitet har understøttet øget genanvendelse frem mod 2025
EKSEMPLER PÅ TILTAG
Tiltag
AFFALD
1.3.1
Adfærdsændrende tiltag for bedre affaldssortering.
1.3.2 Krav til leverandører om, at de kan behandle affaldet bedre og dokumentere det.
Udgangspunkt Målsætning 2025
En stikprøve fra 2021 viste, at 54 % af restaffaldet var egnet til at blive genanvendt, specialbehandlet eller deponeret. Andelen af affald i restaffaldet, der kan sorteres i egen fraktion, bruges som indikator på, hvor godt det går med affaldssorteringen.
46 % af alt affald blev reelt genanvendt i 2022.
2025: Højst 30 % af restaffaldet må være affald, der skulle have været genanvendt, specialbehandlet eller deponeret.
2030: Højst 15 %.
Status 2025
I 2026 gennemføres en målrettet og lokalitetsbestemt analyse, der vil give bedre grundlag for at prioritere handlinger
1.3.3 Fokus på højere datakvalitet.
1.3.4 Udbud af affaldsindsamling- og behandling.
Kvaliteten af affaldsdata fra affaldsaftager varierer og lever ikke altid op til nyeste krav om data for reel behandling.
Mål for den reelle genanvendelsesprocent:
2025: 60 %
2030: 70 %
2035: 75 %
Der er elementer i aftaler med leverandører om affaldsbehandling, logistik og økonomi, der skal videreudvikles for at nå vores ambitiøse målsætninger.
100 % af affaldsdata er baseret på den reelle behandling.
Det har ikke været muligt at indfri målsætninger for 2025, da disse var for optimistiske i forhold til vores forskningsaktiviteter.
2023: 39,0%
2024: 43,4%
2025: 39,4%
Procentsatsen viser CAS’ interne vurdering af hvor stor en del af affaldsmængden, der har en dokumenteret god datakvalitet.
2022: 73 %
2023: 79%
2024: 72%
2025: 76%
Udbud af hhv. farligt affald og ikke-farligt affald er gennemført og implementeret.
Udbud af farligt affald er gennemført. Udbud af ikke-farligt affald igangsættes 2026.
HISTORISK UDVIKLING
Indsatsområde: Reduceret co2-udledning
2.1 Flyrejser
DTU arbejder med at reducere klimabelastningen fra flyrejser og løbende datagrundlag understøtter målsætningen om reduktion pr. fuldtidsansat (FTE) i 2025.
EKSEMPLER PÅ TILTAG
Tiltag Udgangspunkt Målsætning 2025 Status 2025
FLYREJSER
2.1.1 DTU reducerer antal fløjne km pr. FTE.
HISTORISK UDVIKLING
FLYREJSER
8.916 fløjne km pr. FTE, svarende til en CO2-udledning på 1.450 kg pr. FTE (2019)
Antal fløjne km pr. FTE reduceres med 25 %.
40.5% reduktion ift. 2019 baseline
* DTU’s rejsearrangør har korrigeret i antallet fløjne km for tidligere år. For at benytte en sammenhængende beregningsmetode for alle år er der derfor korrigeret i de oplyste faktiske tal.
2.2. Energiforbrug
DTU har reduceret energiforbruget gennem tekniske forbedringer, brugerinvolvering og datadrevet styring.
EKSEMPLER PÅ TILTAG

Tiltag Udgangspunkt Målsætning 2025 Status 2025
REDUKTION AF ENERGIFORBRUG
2.2.1 DTU reducerer energiforbrug pr. studerende og ansat.
Energiforbrug pr. studerende og ansat: 9,8 MWh.
2.2.2
DTU udvikler og implementerer energiledelsessystem.
Foranalyse til projekt er afsluttet.
Målsætning 2025: 5 % reduktion
Målsætning 2030: 10 % reduktion
Ift. baseline (gennemsnit af forbrug i 2017, 2018 og 2019).
Implementeret energiledelsessystem der er certificeret efter ISO 50001-standard.
20,4 % reduktion ift. baseline.
Ekstern audit er gennemført, og certificeringen afsluttes Q1 2026
2.3 Vedvarende energikilder
DTU arbejder med vedvarende energiløsninger på campusserne gennem solcelleanlæg og varmepumper, som bidrager til lavere CO2- udledning og understøtter energiomstillingen.
EKSEMPLER PÅ TILTAG
Tiltag Udgangspunkt Målsætning 2025 Status 2025
VEDVARENDE ENERGIKILDER
2.3.1
DTU reducerer
CO2-udledningen fra energiforbrug pr. studerende og ansat.
2.3.2 Opsætning af forsøgsvindmøller på Risø Campus i regi af Risø Hybrid Power, der kan teste f.eks. grøn energiproduktion, lagring og de systemer, der skal styre fremtidens forsyning. Et såkaldt living lab.
CO2-udledning pr. studerende og ansat: 0,9 ton.
De nationale målsætninger for reduktion af drivhusgasser:
70 % reduktion af drivhusgasser i 2030 ift. indeksår 1990 samt klimaneutralt samfund i 2050.
DTU ’s infrastruktur sikrer, at grundforskning og materialeforskning, udvikling og test har de bedste forudsætninger.
Godkendt klimastrategi og -handlingsplan, inkl. måltal på reduktion af CO2-udledning relateret til DTU’s energiforbrug.
2.3.3 Opsætning af solceller Lyngby campus Anlæggene giver fleksibilitet i forhold til energirammerne i forbindelse med opførelse af nye og modernisering af ældre bygninger
Energiproduktion baseret på vedvarende energikilder svarende til 100 husstande.
Første forskningsprojekter startet i DTU Risø Hybrid Power.
Demoprojekt til National Energy System Transition Facilities (NEST Facilities) afsluttet.
Etablering af solcelleanlæg med en kapacitet på 125 MWh.
Der arbejdes fortsat med at udvikle en strategi for bæredygtighed i FM, herunder klima- og miljø tiltag. Denne strategi inddrager viden fra Baseline projektet, der er et samarbejde mellem DTU CAS og Centre for Absolut Bæredygtighed Projektet skal udvikle indikatorer og en baseline for DTU’s klima- og miljøpåvirkning.
Infrastrukturen til forskningsprojektet er etableret, hvorved test af sammenkobling af vedvarende energikilder og energilagring kan udføres.
2.3.4 Opsætning af varmepumpe på Lyngby Campus.
På Lyngby Campus etableres en varmepumpe, der kan dække 35 % af DTU’s årlige, aktuelle varmebehov ved genbrug af varme fra eget fjernkølesystem.
Varmepumpen forventes at bidrage til en årlig reduktion af CO2-emissioner på 180 ton set i forhold til den eksisterende varmeforsyning.
Etablering af varmepumpen er i gang med henblik på en idriftsættelse i foråret 2026.
Udarbejdet endelig opgørelse for CO2e-besparelse.
Projektet om at etablere solceller der kan øge den årlige produktion med 125 MWh er igangsat. Projektet er under VVM Screening. Der er på det eksisterende anlæg produceret 238 MWh i 2025.
Varmepumpen forventes i drift i Q2 2026.
HISTORISK UDVIKLING
ENERGIFORBRUG PR. STUDERENDE/ÅRSVÆRK
Elforbrug (MWh pr. studerende og ansat)
Varmeforbrug (MWh pr. studerende og ansat)
Energiforbrug, total (MWh pr. studerende og ansat)
CO2-udledning (ton pr. studerende og ansat)
ENERGIFORBRUG (MWH)
Elforbrug (absolut elforbrug inkl. el til forskningsprocesser)
Varmeforbrug (absolut varmeforbrug inkl. varme til forskningsprocesser)
SAMLET CO2-UDLEDNING FRA EL OG VARME A (TON)
CO2-udledning fra samlet energiforbrugB (el og
CO2-UDLEDNING FRA EL PR. LOKATIONC (TON)
CO2-UDLEDNING FRA VARME PR. LOKATION (TON)
A) Emissionsfaktorer brugt til udregning er baseret på foreløbige tal for 2025. De reviderede tal fra forsyningsselskaberne foreligger i Q2 2026
B) CO2-udledning fra elforbrug afspejler det nationale energimix. DTU har indkøbt certifikater for CO2-neutral strøm for det samlede elforbrug.
C) DK-øst (Sjælland og Bornholm er forbundet med Sverige og Tyskland) og DK-vest (Jylland og Fyn er forbundet med Norge, Sverige og Tyskland). Derfor opdeler Energinet Danmark i hhv. Øst og Vest, da der er forskellige energikilder og derfor også forskellige CO2e-udledningsfaktorer for el i Danmark. Det giver et mere retvisende billede at anvende DK-Øst for DTU’s sjællandske lokationer og ditto DK-vest for de jyske.
Område: Campusudvikling og -drift
3.1 Campus, byggeri og bygningsdrift
DTU anvender DGNB - certificering som ramme for arbejdet med byggeri og drift, både i nye projekter, renoveringer og i campusplanlægningen.
EKSEMPLER PÅ TILTAG
Tiltag Udgangspunkt Målsætning 2025 Status 2025
CAMPUS, BYGGERI OG BYGNINGSDRIFT
3.1.1 DTU certificerer efter ’DGNB for nye bygninger og omfattende renoveringer’.
DTU fik i 2021 certificeret de første bygninger jf. DGNBmanualen for nye bygninger og omfattende renoveringer.
Alle nye bygninger er certificeret til minimum DGNB Sølv og Guld for alle bygninger uden laboratoriefaciliteter.
DTU stiler efter DGNB Diamant og Hjerte i relevante byggeprojekter.
Alle nye bygninger er certificeret til minimum DGNB Sølv og Guld for alle bygninger uden laboratoriefaciliteter.
3.1.2
DTU bevarer DGNB plancertificering af Lyngby Campus som byområde ved fortsat at udvikle campus i en mere bæredygtig retning.
DGNB-CERTIFICERING
Nye bygninger og omfattende renoveringer
Nye bygninger:
Lyngby Campus blev DGNBplancertificeret til guld i 2021.
Ballerup Campus er ikke certificeret som byområde.
Bygning 374 certificeret til guld og diamant
Bygning 357 præcertificeret til guld
Bygning 112 præcertificeret til guld.
Nye bygninger:
Bygning 313 præcertificeret til guld
Omfattende renovering: Bygning 116 certificeret til sølv Bygning 208 præcertificeret til guld.
Opretholdelse af DGNBplancertificering af Lyngby Campus på guldniveau.
Afdække, hvorvidt DTU’s øvrige selvejende campusser kan plancertificeres.
Nye bygninger:
Bygning 357: Certificeret til guld
Bygning 112: DGNB Diamant
DGNB byområde plancertificering, for Lyngby Campus, er blevet opretholdt til guld niveau.
Bygning 112; DGNB Guld og Diamant.
Bygning 208: DGNB Platin samt Diamant og Hjerte.
Det forventes, at bygning 313 opnår DGNB Guld i 2026.
3.2 Indeklima
DTU styrker indsatsen for dokumenteret indeklima i eksisterende bygninger, samtidig med at nye bygninger opføres med høje indeklimakrav.
EKSEMPLER PÅ TILTAG
Tiltag
INDEKLIMA
3.2.1 DTU styrker indsatsen for et indeklima af høj kvalitet med minimal miljøpåvirkning, der samtidig understøtter et godt studie- og arbejdsmiljø.
Udgangspunkt Målsætning 2025 Status 2025
Der arbejdes med indeklima ad hoc og efter behov.
I nye bygninger stilles der høje krav til indeklimaet.
Etablering af et system for løbende vurdering af og opfølgning på indeklima i eksisterende bygninger.
80 % af DTU’s undervisningslokaler er udstyret med målesystemer, der opsamler indeklimadata.
Etablering af dataloggere er gennemført. 80 % målet blev opnået i 2024. Der er på baggrund af data fra dataloggere gennemført et masterprojekt ved DTU Sustain, som kortlægger indeklima i undervisningsmiljøerne på Lyngby campus.

3.3 Biodiversitet
DTU arbejder med at øge biodiversiteten på campusserne gennem nye retningslinjer for beplantning, herunder brug af hjemmehørende arter.
EKSEMPLER PÅ TILTAG
Tiltag Udgangspunkt Målsætning 2025 Status 2025
BIODIVERSITET
3.3.1 DTU øger biodiversiteten på campusområderne.
Biodiversiteten på Lyngby Campus blev kortlagt i 2021.
3.3.2 Ved fældning af træer kompenseres med modsvarende skovrejsning.
3.4 Vandforbrug
DTU følger anlægsloven og kompenserer for fældet skov ved anlæg af fx Østerild testcenter.
Naturstyrelsen administrerer aftalen og skal finde 700 hektar til genoprejsning.
DTU har et digitalt dashboard for Lyngby Campus, der muliggør løbende monitorering og optimering af vandforbruget.
EKSEMPLER PÅ TILTAG
Der er lavet målsætning om at 90 pct. nyplantninger skal være hjemmehørende arter.
Desuden er der lavet udkast til ‘Handlingsplan for biodiversitet 20252030’ for DTU Lyngby Campus. Handlingsplanen forventes godkendt medio 2025.
Som kompensation for den skov, der er fældet i Østerild, laves erstatningsskov i forholdet 1,6, dvs. ved rydning af 1 hektar etableres 1,6 hektar ny skov andet sted.
Målet om 90% hjemmehørende arter ved nyplantninger blev opnået i 2024.
Udkast til ‘Handlingsplan for biodiversitet 20262031’ for DTU Lyngby Campus, forventes godkendt medio 2026. Biodiversitetsbaseline er implementeret som del af opstart af landskabsprojekter.
Der er rejst 460 hektar skov ud af de i alt 700 hektar, der skal rejses.
Tiltag Udgangspunkt Målsætning 2025 Status 2025
VANDFORBRUG
3.4.1 DTU reducerer forbrug af vand fra vandværket og øger mængden af opsamlet vand til brug på udendørs arealer.
170.481 m3 svarende til 12,2 m3 pr. studerende og ansat.
Forbruget af vandværksvand er reduceret med 10 % ift. baseline (gennemsnit af 2017-2019).
Vandforbruget pr. studerende og ansat er i 2025 faldet med 20,5 % ift. baseline
DTU har konstateret og udbedret et defekt vandfilter til procesvand. Defekten forklarer stigningen på 10% i vandforbrug i 2025 ift. 2024.
HISTORISK UDVIKLING
VANDFORBRUG
(m3)
Forbrug af vandværksvand pr. studerende og ansat (m3)
3.5 Mobilitet
DTU arbejder med grøn mobilitet gennem forbedret infrastruktur til cyklisme, gang og offentlig transport samt tiltag, der skal begrænse unødig bilkørsel på campus. Derudover udbygges infrastrukturen af ladepunkter til elbiler.
EKSEMPLER PÅ TILTAG
Tiltag Udgangspunkt Målsætning 2025 Status
MOBILITET
3.5.1 Fremme af kørsel i elbil. Der er opsat 100+ ladepunkter på DTU.
3.5.2 Fremme af cyklisme, gang og offentlig transport på Lyngby Campus.
Mobilitet er et centralt tema i de strategiske campusplaner.
Anlægget af Hovedstadens Letbane startede etablering af letbane på Lyngby Campus i 2021.
Der er udarbejdet en tværgående strategi og lokale handlingsplaner for etablering af ladepunkter til elbiler på alle DTU’s campusser.
På Lyngby Campus er der etableret ny infrastruktur og faciliteter til fodgængere og cyklister, der gør det nemt og sikkert at komme rundt på campus, samt til og fra letbanens stoppesteder.
DTU Lyngby har 124 ladepunkter.
Strategi for ladepunkter forventes færdig i 2026.
Opdaterede retningslinjer for cykelfaciliteter er godkendt og handlingsplan er udarbejdet.
Cykelparkering er etableret ved letbanestationen på Anker Engelunds Vej og cykelparkering ved Akademivej etableres Q2 2026.
Bygningsprojekt med cykel kælder i 2. kvadrant er godkendt af bestyrelsen.
3.5.3 Begrænsning af unødig bilkørsel på Lyngby Campus
Mobilitet er et centralt tema i de strategiske campusplaner.
Der er etableret parkeringshenvisning og dynamisk skiltning, der informerer om antal ledige parkeringspladser til de primære parkeringsområder, for at begrænse kørslen efter parkeringspladser.
P-normen for biler er reduceret, og der er igangsat etablering af ny infrastruktur til privatbilisme, der skaber mere plads til gående og cykler.
Parkeringshenvisningsskilte er besluttet og udbudsmaterialet er udarbejdet.
Lokalplansforslag 305 for Lyngby campus er sendt i høring.
Det foreslår reduktion af myndighedskrav med 25 % indenfor et cirkelslag på 300 m fra letbanestationen.
Personale og arbejdsmiljø
PERSONALE
Bæredygtigt arbejdsliv
DTU arbejder dialogbaseret med trivsel gennem en struktureret, løbende dialog baseret på værktøjet DTU Trivselsdialog som afsæt for den psykiske APV. I 2025 blev der i samarbejde med samarbejdsorganisationen gennemført en erfaringsopsamling, som bekræftede, at den dialogbaserede tilgang har været fremsynet. På baggrund heraf er der iværksat flere organisatoriske tiltag, der understøtter enhedernes arbejde med trivsel og ledelse. Der er opbakning til at fortsætte ad dialogens vej, med erkendelsen af, at metoden kræver træning og mod til at sige det højt, der skal handles på. DTU accepterer ikke krænkende adfærd og har i 2025 opdateret sin politik på området. Sager håndteres på det relevante organisatoriske niveau og så tæt på den konkrete situation som muligt. Der er desuden mulighed for anonym registrering gennem DTU’s psykologrådgivning eller whistleblowerordningen.
I 2025 blev DTU’s Ph.d.-vejlederprogram relanceret med et nyt modul om wellbeing og i samarbejde med en ekstern psykolog har der været tilbudt online gruppeforløb for ph.d.-studerende om mental sundhed og støtte i arbejdslivet.
DTU har igangsat et større projekt om psykisk arbejdsmiljø. I 2025 deltog over 50 arbejdsmiljørepræsentanter i et internt todages kursus med fokus på viden og træning i at styrke det psykiske arbejdsmiljø. Neurodiversitet indgik som centralt tema og kobles naturligt til DTU’s DEI-arbejde og ambitionen om en inkluderende kultur, hvor alle oplever, at deres kompetencer bliver værdsat.
ARBEJDSMILJØ
Arbejdsulykker
I 2025 er antallet af fraværsdage efter arbejdsulykker faldet, og ulykkesfrekvensen er fortsat relativt lav. Der blev anmeldt 11 arbejdsulykker, som medførte 42 fraværsdage. Til sammenligning, medførte 12 arbejdsulykker i 2024, 178 fraværsdage.
ARBEJDSULYKKER 2023-2025
Sammenlignet med tidligere år, hvor få alvorlige ulykker resulterede i mange fraværsdage, har 2025 ikke haft tilsvarende alvorlige ulykker. Blandt de 11 anmeldte arbejdsulykker, var knap halvdelen faldulykker, som førte til forstuvninger eller knoglebrud.
Det samlede antal registrerede nærved-hændelser på DTU er steget i forhold til 2024. I 2025 blev der registreret 98 nærved-hændelser mod 66 i 2024. Stigningen skyldes øget fokus fra universitetsenhederne på at registrere disse hændelser, hvilket vurderes positivt.
Beredskab
DTU’s beredskab arbejder målrettet på at skabe et trygt og sikkert universitet gennem strategisk kapacitetsopbygning. Det sker blandt andet via myndighedsbetjening, opbygning af netværk, håndtering af akutte hændelser og beredskabsplanlægning. I 2025 har DTU´s sikkerhedsudvalg (SiFI) nedsat et Emergency Management Forum, som har til formål og opgave at opbygge krise-hånderingskapacitet ved at samle relevante personer på tværs af DTU’s organisation, som kan indgå i en pulje af bidragsydere til krisehåndtering.
Som en del af beredskabsindsatsen, er der i 2025 gennemført en systematisk kortlægning af den aktuelle tilstand for alle sikringsrum på DTU Lyngby Campus. Det administrative ansvar for sikringsrummene påhviler kommunerne, og der gennemføres i øjeblikket et landsdækkende eftersyn af deres tilstand. Sikringsrum kan midlertidigt anvendes
Skader uden fravær
Nærved ulykker Studerende
Skader med fravær
til formål som opbevaring, under forudsætning af at rummet kan ryddes og klargøres inden for en kort tidsramme. Derudover er der i 2025 arbejdet videre med at højne sikkerheden for deltagerne ved større og mindre arrangementer på DTU. Hertil er der implementeret en skabelon for sikkerhedsplan, som anvendes ved alle større arrangementer. Sikkerhedsplanen følger dels myndighedernes retningslinjer for området og motiverer arrangøren til at have en risikobaseret tilgang ift. planlægning af arrangementer.
Sygefravær
Det gennemsnitlige sygefravær på DTU ligger på et stort set uændret niveau. Med DTU’s fleksibilitetspolitik er der fortsat fokus på, at man kan arbejde hjemmefra ved lettere sygdom. Dette letter sygdomsforløb og skåner kollegaer fra at blive smittet
PERSONALEDATA
Aldersprofil på VIP og TAP I tabellerne nedenfor er angivet aldersprofilen for universitetets ansatte fordelt på stillingskategori samt kvindeandelen i Faculty. Både timelønnede og månedslønnede indgår.
Aldersfordeling og gennemsnitsalder er beregnet på baggrund af antal personer ansat pr. december 2025 og alderen på dette tidspunkt.
* Note: Faculty omfatter stillinger med undervisningsforpligtelse, og hvor undervisningsforpligtelsen udgør mellem 20-50 pct. af arbejdstiden. Professorer og professor MSO indgår pr. januar 2019 dog altid i Faculty uanset undervisningsforpligtelse
Kvindeandele i
PERSONALEDATA (BÅDE TIMELØNNEDE OG MÅNEDSLØNNEDE INDGÅR)
Stillingskategorier
LEDELSE
og centredirektør
Heraf enheder, hvor DTU er eller har været værtsuniversitet (Danske Universiteter, UNIIT inkl. nyt SIS, DeiC og Forskningsnettet)
Både timelønnede og månedslønnede indgår DVIP består af censorer, undervisningsassistenter, eksterne lektorer og hjælpelærere Medarbejdere med en lederstilling indgår i gruppen "Sektionsledelse", mens øvrige special- og chefkonsulenter indgår i gruppen "Akademikere"
Bestyrelsen og direktionen
MEDLEMMERNES BESTYRELSESPOSTER
I SELSKABER, FONDE M.V.
BESTYRELSEN
Ulrik Juul Christensen
Bestyrelsesformand for Area9 Lyceum og medlem af bestyrelsen for Global Underwater Explorers
Henrik Clausen
Medlem af Dansk Erhvervs forretningsudvalg
Marianne Dahl
Medlem af bestyrelsen for Telenor, Tieto, Continia og Det Udenrigspolitiske Selskab
Kasper Moth-Poulsen
Medlem af bestyrelsen for ConScience AB, Nanoscientifica Scandinavia AB og AutoSyn AB
Charlotte Rønhof
Bestyrelsesformand for Bornholms Erhvervsfond, medlem af bestyrelsen for Hjerteforeningen, Innovationsfonden, Katafonden og SEGES Innovation.
Nina Kjærgaard Hendel
Medlem af DM’s sektorbestyrelse
DIREKTIONEN
Anders Overgaard Bjarklev
Formand for bestyrelsen for Virum Gymnasium. Medlem af bestyrelserne for Teknologisk Institut, Fonden for Entreprenørskab, Færøernes Universitet og Lunds Universitet.
Ex officio formand for og medlem af et antal andre fondsbestyrelser.
Herudover ex officio medlem af bestyrelser for en række andre organisationer og samarbejdsfora, herunder internationale.
Christine Nellemann
Forperson for Det Etiske Råd.
Danmarks Forsknings- og Innovationspolitiske Råd (DFIR).
Forperson for Forskningspolitisk Udvalg under Danske Universiteter.
Claus Nielsen
Medlem af bestyrelserne for Klimafonden Skive samt Nordsøens Forskerpark.
Ex officio formand for bestyrelsen for Dianova A/S, bestyrelsen for Boligfonden DTU og bestyrelsen for Hempel Kollegie Fonden.
Medlem af bestyrelserne for Nordvej Vest PS, Nordvej Vest 2018 ApS og DTU-datterselskabet
DTU Science Park A/S.
Herudover ex officio medlem af bestyrelser for en række fonde og organisationer.
Lars D. Christoffersen
Formand for bestyrelsen for Egedal Gymnasium og HF.
Medlem af bestyrelsen for Technical Education Copenhagen (TEC).
Medlem af bestyrelsen i Spottet, Skive Medlem af bestyrelsen for Akademiet for Talentfulde
Unge, øst
Ex officio medlem af adskillige fondsbestyrelser
Carsten Orth Gaarn-Larsen
Københavns kommunes Erhvervsråd. Sjællands Udviklingsalliance.
ECHO.
Næstformand for bestyrelsen for Siemens Fonden. Næstformand i ”Guide til resilient Danmark”, (ATV).
Medlem af Akademiet for de Tekniske Videnskaber (ATV). VL20.
Marianne Thellersen
Næstforperson i bestyrelserne for DTU’s datterselskaber
Bioneer A/S, DFM A/S og Teknisk Universitetshospital.
Derudover ex officio medlem af bestyrelserne for DTU’s datterselskaber
DTU Science Park A/S, PreSeed Ventures A/S og Dianova A/S.
Camilla Rygaard-Hjalsted
Viceforperson i DFM – Dansk Fundamental Metrologi A/S.
Medlem af bestyrelsen i MADE - Manufacturing Academy of Denmark.
Medlem af styrekomiteen i MHI - Microbiome Health Initiative. Medlem af bestyrelsen i Energy Cluster Denmark.
Medlem af bestyrelsen i DARA – Danish Advanced Research Academy.
Medlem af bestyrelsen i Food & Bio Cluster Denmark.
Forperson i styrekomiteen i Centre for Nuclear Energy Technology, DTU.
Forperson i styrekomiteen i Centre for Absolute Sustainability, DTU.

Seniorforsker Elizaveta Semenova fra DTU dyrker unikke nanokrystaller, der udsender fotoner direkte i telekommunikationsstandardens frekvensområde. Det betyder, at kvanteinformation kan sendes gennem eksisterende fiberkabler med minimale tab og uden behov for omdannelse af signalerne. I DTU Nanolab integrerer hendes team de skrøbelige kvantelyskilder i skalerbare chips ved hjælp af mikro transfer printing, som placerer hver enhed præcist dér, hvor den skal interagere med chippens kredsløb. Teknologien indgår i et stort europæisk samarbejde, hvor forskere lag for lag bygger de første kvantechips af sin slags.
DTU ÅRSRAPPORT 2025
APRIL 2026
ISSN 1603-1784
REDAKTION
MATHILDE HØJRING
PRODUKTION STIBO COMPLETE
FOTOS MAGNUS MØLLER, BAX LINDHARDT, LINNEA LUNDBERG, DAVID STJERNHOLM, MARIE BENTZON, FRANK
UNDALL, DITTE VALENTE, MORTEN OLIVARIUS, NASRIN BILLIE, ARNAJARAQ STØVLBÆK, THOMAS STEEN SØRENSEN, GIA KLEIST-LUNDBLAD, PERNILLE BAK ANDREASEN, KYV GRØN, LASSE BECH MARTINUSSEN, SUND & BÆLT, DTU.
Anker Engelunds Vej 1 Bygning 101A 2800 Kgs. Lyngby dtu.dk
Danmarks Tekniske Universitet